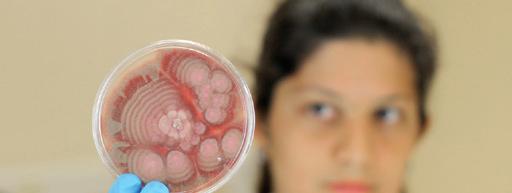

Transformando conocimiento Centro Nacional de Alta Tecnología en desarrollo











MEMORIA CeNAT 2023



Transformando conocimiento
Centro Nacional de Alta Tecnología en desarrollo

MEMORIA CeNAT 2023


303 483
C755m Consejo Nacional de Rectores Centro Nacional de Alta Tecnología
Memoria CENAT 2023 : transformando conocimiento en desarrollo [Recurso electrónico] / Centro Nacional de Alta Tecnología – Datos electrónicos (1 archivo : 34 mb) -- San José, C R : CONARE - OPES, 2024
ISSN 2215-6925
Formato pdf, (198 páginas )
1 INFORME DE LABORES 2 CIENCIA Y TECNOLOGÍA 3 DESARROLLO CIENTÍFICO Y TECNOLÓGICO 4 CONSEJO NACIONAL DE RECTORES CENTRO NACIONAL DE ALTA TÉCNOLOGÍA 5 COSTA RICA I Título
Presentación CeNAT
Nuestras Áreas, Laboratorios y Programas
Laboratorio Nacional de Nanotecnología (LANOTEC)
Laboratorio CENIBiot
Colaboratorio Nacional de Computación Avanzada (CNCA)
Laboratorio PRIAS
Área Gestión Ambiental
Resultados Institucionales
Indicadores de la Labor Institucional FunCeNAT y Resultados Financieros
Liderazgo Institucional
4-5 18-37 6-17 38-56 57-72 73-89 90-107 108-124 125-161 162-165 166-173 174-193
acrónimos Siglas y

CONARE
CeNAT
PRIAS
LANOTEC
CNCA
CENIBiot
CREATEC
TEC
UCR
UNA
UNED
UTN
Edu-Roam
LACOMET
USAID
BCCR
CCSS
PROMOTORA
ICE
INA
INEC
MAG
MICITT
MINAE
RREE
FEES
SAF
PILA
UdelaR
CONICET
UBA
CNEA
Univalle
UNI
CNRS
UGA
TGA
FTIR
SEM
TEM
CANAPEP
IJSO
Consejo Nacional de Rectores
Centro Nacional de Alta Tecnología
Laboratorio PRIAS
Laboratorio Nacional de Nanotecnología
Colaboratorio Nacional de Computación Avanzada
Laboratorio Centro Nacional de Innovaciones Biotecnológicas
Programa de Creatividad y Emprendimiento en Alta Tecnología
Instituto Tecnológico de Costa Rica
Universidad de Costa Rica
Universidad Nacional
Universidad Estatal a Distancia
Universidad Técnica Nacional
Education Roaming
Laboratorio Costarricense de Metrología
Agencia de los Estados Unidos para el Desarrollo Internacional
Banco Central de Costa Rica
Caja Costarricense de Seguro Social
Promotora Costarricense de Innovación e Investigación
Instituto Costarricense de Electricidad
Instituto Nacional de Aprendizaje
Instituto Nacional de Estadística y Censos
Ministerio de Agricultura y Ganadería
Ministerio de Ciencia, Innovación, Tecnología y Telecomunicaciones
Ministerio de Ambiente y Energía
Ministerio de Relaciones Exteriores y Culto Fondo Especial para la Educación Superior
Sistemas Agroforestales
Parque Internacional La Amistad
Universidad de la República de Uruguay
Consejo Nacional de Investigaciones Científicas y Técnicas
Universidad de Buenos Aires
Comisión Nacional de Energía Atómica
Universidad del Valle, Colombia
Universidad Nacional de Ingeniería, Perú
Centre National de la Recherche Scientifique, Francia
Universidad de Grenoble Alpes, Francia
Termogravimetría
Espectroscopia Infrarroja por Transformada de Fourier
Microscopía Electrónica de Barrido
Microscopía Electrónica de Transmisión
Cámara Nacional de Productores y Exportadores de Piña
Internacional Junior Science Olympiad
COLAEIQ
ACOMET
INS
AFM
Congreso Latinoamericano de Estudiantes de Ingeniería Química y Carreras Afines
ACOMET Metales y Minerales S.L.
Instituto Nacional de Seguros
Microscopía de Fuerza Atómica
1

QUIMICAM
ECMAR
ICHO
NAVAL
INALVE
FIFCO
ULEAD
NASA
NOAA
USGS
ESA
DLR
ILSI Mesoamérica
STEAM
ALLBIOTECH
DOS PINOS
PINN
CITA
INTA
AECID
TUHH
Campamento de Química
Estación Nacional de Ciencias Marino-Costeras
Olimpíada Internacional de Química
NAVAL de los Estados Unidos
Inalve Industrias Alimenticias
Florida Ice and Farm Company
Universidad LEAD
Administración Nacional de la Aeronáutica y del Espacio
Administración Nacional Oceánica y Atmosférica
Servicio Geológico de los Estados Unidos
Agencia Espacial Europea
Agencia Espacial Alemana

Asociación ILSI Mesoamérica

CORBANA
BIOTECH
SEVRI
PAO

Ciencia, Tecnología, Ingeniería, Arte y Matemática
Red latinoamericana de jóvenes Líderes en Biotecnología
Cooperativa de Productores de Leche Dos Pinos R.L.
Programa de Innovación y Capital Humano para la Competitividad
Centro Nacional de Ciencia y Tecnología de Alimentos
Instituto Nacional de Innovación y Transferencia en Tecnología Agropecuaria
Agencia Española de Cooperación Internacional para el Desarrollo
Universidad de Tecnología de Hamburgo, Alemania
Corporación Bananera Nacional
Biotecnología



Sistema Específico de Valoración de Riesgo Institucional Plan Anual Operativo






2

3

Eduardo Sibaja Arias
Director
Centro Nacional de Alta Tecnología
CeNAT
contribuyendo a la investigación y la innovación para beneficio del país
Han transcurrido 25 años desde que el Gobierno de la República (1994-1998) y el Consejo Nacional de Rectores impulsaron la creación del Centro Nacional de Alta Tecnología. Ese esquema se inspiró en un modelo implementado en países como Corea, Japón, Malasia, Singapur e Israel, el cual ligaba explícitamente al gobierno, las universidades y las empresas de alta tecnología para formar una alianza tripartita enfocada en la investigación científico-tecnológica y en la innovación como ejes dinamizadores de la economía.
En medio de este panorama se empezó a gestar un sueño que hoy, 25 años después, es una realidad: el Centro Nacional de Alta Tecnología (CeNAT), programa creado por el Consejo Nacional de Rectores (CONARE) en la sesión N° 5-99 del 2 de marzo de 1999 como un “órgano interuniversitario especializado en el desarrollo de investigaciones y posgrados en áreas de alta tecnología y el desarrollo de proyectos de vinculación e innovación tecnológica con el sector gubernamental y empresarial”.
A través de estas más de dos décadas, el CeNAT del CONARE ha desarrollado una amplia experiencia en investigación, gracias al trabajo de sus cuatro laboratorios: Laboratorio PRIAS, Laboratorio Nacional de Nanotecnología (LANOTEC), Laboratorio CENIBiot, Colaboratorio Nacional de Computación Avanzada (CNCA) y el Área de Gestión Ambiental.
Todos ellos enfocan su trabajo en la investigación y en la innovación, para transformar conocimiento científico y tecnológico en desarrollo.
Estos años de logros y retos, hemos implementado instrumentos de rendición de cuentas que fortalecen los procesos de transparencia. Uno de ellos es la Memoria Anual que recopila la gestión del CeNAT y cada dependencia, lo que permite medir el grado de eficiencia y eficacia de nuestra labor.
Para esta Memoria 2023 presentamos las cifras de la gestión institucional. En este año el CeNAT registró 95 proyectos desarrollados en el marco de la triple hélice (academia, gobierno y sector privado); 157 transferencias de conocimiento; 66 publicaciones científicas; asistencia técnica a más de 9.000 productores; apoyo a 28 organismos o instituciones de investigación ciencia aplicada; apoyo a 45 empresas de investigación ciencia aplicada; 7 olimpiadas y ferias científicas en las que se brindó apoyo; 85.363 horas ciencia en simulaciones y procesamiento de datos, entre otros indicadores de gestión.
4


Nuestro trabajo no sería posible sin el respaldo del Consejo Nacional de Rectores (CONARE) y a las alianzas con socios estratégicos como la Universidad de Costa Rica (UCR), el Instituto Tecnológico de Costa Rica (TEC), la Universidad Nacional (UNA), la Universidad Estatal a Distancia (UNED), la Universidad Técnica Nacional (UTN), el Ministerio de Ciencia , Innovación, Tecnología y Telecomunicaciones (MICITT), el anterior Consejo Nacional para Investigaciones Científicas y Tecnológicas (CONICIT), actualmente Promotora Costarricense de Innovación e Investigación (Promotora); entre muchas otras instituciones, empresas y centros de investigación de gran renombre tanto nacionales como internacionales.
Al presentar esta Memoria y los resultados de nuestra gestión en el marco del 25 aniversario nos invita a la reflexión para mantener una correspondencia con la realidad y estar a la altura de las exigencias de estos tiempos marcando muy claramente la hoja de ruta.

Durante este período se ha logrado consolidar al CeNAT como un centro único tanto en Costa Rica como en la región. Nuestros indicadores de gestión reflejan el compromiso con la excelencia, además nos retan a seguir creciendo y continuar por la senda de la mejora continua, contribuyendo al fortalecimiento de la ciencia y la tecnología, además de ayudar a cultivar las vocaciones científicas en las futuras generaciones como una meta fundamental país.
5



Antecedentes del CeNAT



La iniciativa para la creación de un Centro Nacional de Alta Tecnología en Costa Rica, con el respaldo de las universidades estatales, para la atracción de inversión en alta tecnología; por el papel que desempeña la academia, como la principal generadora de investigación en Costa Rica, se dio en el año 1997 durante la administración Figueres Olsen.
Por lo anterior, en octubre de 1997, el Gobierno de la República presentó al Consejo Nacional de Rectores (CONARE) la iniciativa para destinar el inmueble utilizado por la antigua Agencia de los Estados Unidos para el Desarrollo Internacional (USAID) para la constitución de un centro de carácter nacional en alta tecnología, mediante el cual la academia se vinculara con el sector productivo en áreas de alto impacto asociadas a la atracción de la inversión extranjera, en beneficio del desarrollo nacional. La propuesta tomaba de referencia países como Corea, Singapur e Israel, este último con el Technion o Instituto Tecnológico Israelí, ubicado en Haifa.




El 25 de mayo de 1998, la Asamblea Legislativa promulgó la Ley 7806, autorizando el traspaso del inmueble al CONARE para crear el Centro Nacional de Alta Tecnología (CeNAT) y se denominó al edificio Dr. Franklin Chang Díaz. Además, la Ley promulgada definió, en su artículo 3º, la creación de la Fundación Centro de Alta Tecnología (FunCeNAT), cuyo propósito es mantener el deber legal de administrar los recursos requeridos para la ejecución de los proyectos desarrollados por medio del CeNAT.



6
Consecuentemente, el CONARE, bajo el amparo del Convenio de Coordinación de la Educación Superior Universitaria Estatal, en la sesión número 5-99, del 2 de marzo, 1999 creó el CeNAT.


En esa coyuntura el CONARE apoyó la propuesta de crear un centro de desarrollo científico y tecnológico, lo que potenciaría los esfuerzos en investigación de las universidades.
De esta manera, se conformó el CeNAT como un espacio interuniversitario de encuentro entre la academia, el Gobierno y los sectores productivos del país en diferentes campos de alta tecnología, uniendo esfuerzos para potenciar las posibilidades del país y estar en capacidad de aprovechar las oportunidades que el desarrollo tecnológico brinda a países que, como Costa Rica, han invertido significativamente en la educación de su población en todos sus niveles.
Durante estos años de existencia el CeNAT ha consolidado una plataforma de trabajo basada en la alta capacidad técnica-profesional del personal de sus áreas y laboratorios, sus equipos e instalaciones, la cual le ha permitido impulsar diversos proyectos de investigación y transferencias de conocimiento, enfocados en la visión de transformar conocimiento en desarrollo.
7
Planificación Estratégica


El año 2023 fue un año importante en el tema de la Planificación Estratégica. El CeNAT contaba con el marco filosófico del Plan Estratégico y los Planes Estratégicos de sus laboratorios actualizados 2019-2023, con una misión, visión y objetivo de desarrollo que orientan el andar de la institución durante el presente quinquenio. No obstante, este marco filosófico debía actualizarse y ajustarse a las nuevas realidades.


















8


Por este motivo durante el año 2023 se trabajó los nuevos Planes Estratégicos del CeNAT y sus laboratorios para el quinquenio 2024-2028, por medio de un proceso de consulta permanente y de trabajo en equipo que permitió a cada uno de los laboratorios describir el marco filosófico de su plan estratégico del CeNAT: CENIBiot, LANOTEC, CNCA, PRIAS y el Área de Gestión Ambiental. A la luz de los lineamientos del PLANES, se valoró en el diagnóstico el tema de Regionalización y Objetivos de Desarrollo Sostenible (ODS).


La madurez del proceso determinó que cada laboratorio tiene una naturaleza diferente de emprender su gestión sustantiva, por ello, se solicitó a la consultoría profundizar en los siguientes aspectos:
Realizar un diagnóstico de la percepción organizacional del CeNAT.
Definir orientaciones para abordar líneas organizacionales de cada Laboratorio.
Revisar el marco filosófico del Plan Estratégico 2019-2023.
Planificar las acciones sustantivas de cada laboratorio.
Lograr un índice que identifique los indicadores de la actividad sustantiva de cada instancia.
Lograr un índice que especifique los indicadores de seguimiento al financiamiento.
Integrar cada uno de los marcos filosóficos a las áreas de cada laboratorio al Plan Estratégico del CeNAT.
Cada uno de los puntos enunciados fueron trabajados en forma participativa con las direcciones del área y laboratorios, integrando en las discusiones a profesionales líderes e informantes claves que fueron validando el avance de cada aspecto expresado.
9

CENTRO NACIONAL DE ALTA TECNOLOGÍA
Transformando conomiento en desarrollo

Misión del CeNAT
“Somos un órgano de coordinación interuniversitaria que facilita y promueve el adecuado funcionamiento y el desarrollo sistémico de la investigación científica en la educación superior, en diversas áreas de alto contenido científico–tecnológico, orientado al desarrollo de la investigación, la vinculación y extensión en el marco de innovación, el desarrollo con el sector público y el sector privado con un alcance nacional e internacional.”
Visión del CeNAT
“Ser un Centro líder e innovador que genera conocimiento de alta tecnología en el fomento de la competitividad, promoviendo espacios de publicación científica, transferencia de aprendizaje, fortaleciendo el intercambio del conocimiento al más alto nivel científico y potenciando los mecanismos que apoyen la coordinación interuniversitaria e institucional eficiente y transparente a nivel nacional e internacional.”.
Además de la misión y visión, el CeNAT incorpora en el marco filosófico el objeto de desarrollo, como un aporte del Centro al desarrollo del país.
Objetivo de desarrollo
Ejecutar actividades de investigación que permitan proveer al país de la tecnología necesaria, pertinente y estratégica para un desarrollo competitivo de los diferentes sectores de la sociedad, en el ámbito económico, social y ambiental, mediante la innovación, desarrollo, capacitación y servicios en ciencia y tecnología. (Basado en el acta constitutiva del CeNAT).
10
Objetivo General
Ejecutar actividades de capacitación y de investigación que permitan proveer al país de la tecnología necesaria, pertinente y estratégica para un desarrollo competitivo de los diferentes sectores de la sociedad en los ámbitos económico, social y ambiental.

Objetivos del CeNAT
Los objetivos nacen del acta constitutiva del CeNAT, la cual orienta el quehacer de la institución, su aporte y las áreas que debe atender para el impacto del ejercicio científico.

Objetivo Específicos
Los objetivos específicos describen las grandes categorías que nacen del acta constitutiva hacia donde están orientados para colaborar con el desarrollo científico del país.
11





Respecto a la promoción de la ciencia
Promover la relación de actividades de investigación que permita proveer al país de la tecnología necesaria, pertinente y estratégica para un desarrollo competitivo de los diferentes sectores de la sociedad en los ámbitos económico, social y ambiental.
Realizar todo aquello que signifique bienestar social, cultural y científico concordante con el quehacer de la institución o lo estipulado en el artículo primero de la Ley de Fundaciones.
Respecto a la información y formación
Promover la creación y dar aportes para el sostenimiento de espacios para la reflexión, así como coordinar acciones que apoyen el desarrollo científico y tecnológico y la formación de grupos multidisciplinarios de investigadores de una alta formación y experiencia (alto nivel de masa crítica), especialmente a nivel de posgrado.
Promover la extensión tecnológica, mediante exposiciones, congresos, seminarios, mercados tecnológicos, cursos de capacitación, entre otros.

12

Respecto al aporte en las especializaciones de posgrado
Promover y apoyar la realización de programas académicos de investigación a nivel de posgrado en forma coordinada con las instituciones de educación superior universitaria estatal.
Respecto al aporte al desarrollo país
Respecto a la articulación intersectorial

Promover la coordinación de los sectores público y privado involucrados en la generación, capacitación, transferencia y aplicación de la alta tecnología.
Fomentar e impulsar la generación de empresas de un alto contenido tecnológico y alto valor agregado para el país.
Desarrollar con propósitos de investigación actividades de desarrollo, licenciamiento, contratación de explotaciones (Know-how), donación o compra de patentes, invenciones, modelos industriales o de utilidad.

Divulgar y vender publicaciones derivadas de sus investigaciones, ceder, vender, traspasar y conceder licencias de explotaciones de sus patentes, modelos industriales o de utilidad, así como cualquier otro de los activos que integre su propiedad intelectual.



















































13
Valores y principios presentes en el CeNAT


Los valores que se exponen son señalados por parte del CONARE, posteriormente se exponen los valores y principios presentes en el CeNAT.


CONARE
Valores institucionales de Comunicación
Planificación
Calidad Transparencia





14
Valores presentes en el
CeNAT
Disposición a la excelencia en el trabajo que se emprende
Transparencia en el ejercicio de la investigación
Tolerancia y flexibilidad en el proceso de investigación
Actitud de aprendizaje permanente
Posición de crítica y autocrítica para enfrentar las mejoras en los procesos de investigación
Mantener un espíritu de superación personal permanente a nivel científico

Principios presentes en el CeNAT

Trabajo colaborativo e integrado en todos los procesos
Rigor científico en los estudios que se emprenden
Trabajo desde la complejidad interdisciplinaria
Comunicación efectiva

Responsabilidad en metas y tiempos adquiridos en cada tarea
Compromiso con la generación de impacto en las acciones que se emprenden

15



Áreas
Estratégicas del CeNAT

Las líneas estratégicas están presentes en el quehacer sustantivo del CeNAT, se definen como áreas de desarrollo estratégico de cada laboratorio y sus Programas.

Ciencias e ingeniería de materiales
Gestión Ambiental Bio-tecnología
Computación avanzada
LANOTEC CENIBiot CNCA PRIAS Agromática C. climático
Ciencias de la vida
Norma y regulaciones
Vocaciones Científicas
Agricultura sostenible
Comunicaciones microbianas
Bioprocesos
Descubrimiento de fármacos

Inteligencia Artificial
Bioinformática
Computación de Alto Rendimiento
Computación Científica
Ciencia de Datos
Redes Avanzadas
Infraestructura
Gestión Geoespacial
Desarrollo
Geoinformático
Catalización
Aeroespacial
Variabilidad y cambio climático
Agromática
Energías limpias

Estas áreas de desarrollo permiten observar la importancia del trabajo colegiado de cada una de las dependencias que integran la organización, donde cada una de las acciones aportan en la eficiencia y proyección.
16
Líneas
Estratégicas del CeNAT
Las líneas estratégicas están presentes en el quehacer del CeNAT, se definen como líneas transversales de las actividades sustantivas que realizan los laboratorios y el Área de Gestión Ambiental.
Estas líneas estratégicas permiten observar la importancia del trabajo colegiado de cada una de las dependencias que integran la organización, donde cada una de las acciones aportan en la eficiencia y proyección.

A continuación, se identifican las líneas estratégicas y su definición.
Generación del conocimiento:
Proveer de conocimiento al país en temas de alta tecnología pertinente y estratégica para el desarrollo competitivo de los diferentes sectores de la sociedad en el ámbito económico, social y ambiental.
Transferencia del aprendizaje:
Sostener espacios de aprendizaje desde la coordinación interuniversitaria para articular acciones que apoyan el desarrollo científico, tecnológico y la formación de grupos multidisciplinarios de investigadores de un alto rigor científico.
Internacionalización:
Fortalecer el intercambio de conocimiento del más alto nivel nacional e internacional, tanto en el sector público y privado.
Gestión Institucional:
Potenciar la gestión organizacional por medio de mecanismos que apoyen la sostenibilidad de CeNAT en forma eficiente y transparente de la rendición de cuentas y el desarrollo de la pertinencia científica.
17






Nuestras áreas, laboratorios y programas







Áreas
Ciencia e Ingeniería de Materiales
Biotecnología
Computación Avanzada
Manufactura
Gestión Ambiental
Ciencia, Cultura y Sociedad
Laboratorios
Laboratorio Nacional de Nanotecnología (LANOTEC)
Laboratorio CENIBiot
Colaboratorio Nacional de Computación Avanzada (CNCA)
Laboratorio PRIAS
Programas
Observatorio Climático
Agromática
CREATEC
Becas CeNATCONARE Cátedra CeNAT
19

Área de Biotecnología:
II. Área de Computación Avanzada:
Desde el año 2013, el Laboratorio CENIBiot integra está área operativa.
CeNAT-CONARE.
Área de Gestión Ambiental (AGA):
En esta área se inscriben un laboratorio y dos programas:
III. Área de Manufactura:
A esta pertenece el Colaboratorio Nacional de Computación Avanzada (CNCA), desde el 2009.
IV.
No se tiene unidad operativa adscrita.
VI. Laboratorio PRIAS: Inició desde el año 2003.
Programas:
Observatorio de Variabilidad y Cambio
Climático: Inició a partir del año 2010.
Agromática, Seguridad Alimentaria y Slow Food: Inició su trabajo en el 2010.
20
10 años Laboratorio CENIBiot
13 años Programas: Observatorio de Variabilidad y Cambio Climático Agromática, Seguridad Alimentaria y Slow Food
14 años Colaboratorio Nacional de Computación Avanzada (CNCA)
19 años Laboratorio Nacional de Nanotecnología (LANOTEC)
20 años Laboratorio PRIAS





CeNAT 2023
1998
2013 2010 2009 2004 2003 21
(25 años)


FunCeNAT
Junta Administrativa
Dirección Ejecutiva

Desarrollo organizacional del CeNAT


CONSEJO NACIONAL DE RECTORES
Consejo científico compuesto por vicerrectores de investigación del CONARE

Director General del CeNAT
FunCeNAT
Servicios de Gestión Administrativa
Servicios de Gestión Financiera
Servicios de Gestión Legal
Servicios de Gestión Talento Humano
Servicios de Gestión Comunicación
Asesoría y Gestión Estratégica
Articulación Internacional
Equipamiento Alta Tecnología
Comunicación estratégica científica
FunCeNAT no pertenece a la estructura del CeNAT, su rol es prestar servicios y soporte en la gestión administrativa, financiera y legal.
Ciencia e Ingeniería de Materiales Biotecnología Computación Avanzada Gestión Ambiental
LANOTEC CENIBiot CNCA PRIAS ÁREA DE GESTIÓN AMBIENTAL
Ciencias de la vida
Norma y regulaciones
Vocaciones Científicas
Agricultura sostenible
Comunidades microbianas
Bioprocesos
Enfermedades metabólicas
Inteligencia Artificial
Gestión Geoespacial
Ciencia, Cultura y Sociedad
Programas Programas
Computación de Alto
Rendimiento
Computación Científica
Ciencia de Datos Bioinformática
Redes Avanzadas
Infraestructura
Desarrollo Geoinformático
Catalización Aeroespacial
Variabilidad y cambio climático
Agromática
Energías limpias
Seguimiento a los indicadores de Gestión organizacional de los laboratorios y el Área de Gestión Ambiental
Seguimiento a los indicadores de Sostenibilidad organizacional de los laboratorios y el Área de Gestión Ambiental
Cátedra CeNAT CREATEC
Becas CeNATCONARE
22








Las acciones de la Dirección del CeNAT, están alineadas a las definidas en el acta constitutiva del Centro Nacional de Alta Tecnología, esto es: “Velar por el correcto desempeño del CeNAT, siguiendo las directrices dictadas por el CONARE y las líneas estratégicas delimitadas por el Consejo Científico.”



La base fundamental del trabajo de la Dirección es velar por los temas estratégicos del Centro, tales como:




Seguimiento e implementación de acuerdos y convenios del CeNAT
Establecer las tácticas operativas y metas a desarrollar por la organización.
Supervisión del área de Ciencia, Cultura y Sociedad, la cual integra los programas: Dar seguimiento permanente a las acciones que realiza cada área y programa adherido al CeNAT. Cátedra CeNAT, Becas CeNAT-CONARE.




23







Resultados del CeNAT

Cantidad de publicaciones realizadas
Cantidad de transferencias de conocimiento realizadas
Cantidad de proyectos ejecutados oportunamente
Convenios concretados

Acompañamiento a estudiantes en proyectos de desarrollo académico



Para el CeNAT el año 2023, en cuanto a logros técnicos, fue un año muy productivo en publicaciones, investigaciones y transferencias de conocimientos, entre otros, lo cual permite aportar al desarrollo de la sociedad.



INDICADOR CUMPLIMIENTO l SEMESTRE ll SEMESTRE TOTAL
Porcentaje de acciones esenciales y operativas 58 139 64 12 156 443 8 18 31 2 21 181 66 157 95 14 177 624 24
Cátedra
Una de las áreas del CeNAT es la de Ciencia, Cultura y Sociedad, donde se ubica el tema de la Cátedra CeNAT.i
En este programa se visualizan las actividades de transferencia de conocimientos. En este sentido, desde la Cátedra CeNAT, se organizan charlas, talleres y conferencias orientadas a diferentes sectores de la sociedad, el gobierno y la academia, impartidas por expertos nacionales e internacionales de primer orden mundial, vinculados con actividades y/o proyectos del CeNAT, en temas científicos y tecnológicos. Durante el 2023 no se impartió la Cátedra CeNAT.
25
Charlas Relevantes: LANOTEC
El año 2023 permitió la participación en charlas relevantes, las cuales se citan a continuación:

Modulation, analysis and application of surface chemistry: a collection of stories
La charla fue llevada a cabo de forma presencial en el Departamento de Ciencia de Materiales de la National Yang Ming. El evento fue organizado por el Prof. Hsin-Chieh Lin. La charla fue impartida por el investigador Sergio Paniagua el 20 de enero del 2023.
The Scientific Collaboration of LANOTEC in the Area of Polymers and Bioplastics
Charla: webinario internacional CINDE: Bioprocesamiento, Microalgas y Bioempaque/Bioplásticos. El evento fue llevado a cabo de forma virtual y fue organizado por CINDE. La exposición fue desarrollada por el investigador Diego Batista el 28 de febrero de 2023.
La Biotecnología: motor para el desarrollo social y económico en Costa Rica
Participación en el evento CRBiomed: Clúster de Biotecnología y Ciencias de la Vida. El Evento fue llevado a cabo de forma virtual y fue organizado por CRBiomed. La conferencia fue impartida por el director del LANOTEC, José Vega el 9 de junio de 2023.
Aplicaciones de nanotecnología e impresión 3D
El 29 de agosto del 2023 fue llevado a cabo el evento “Feria de Ciencias para la niñez” de forma presencial. El evento fue organizado por la subcomisión de Promoción de la Investigación de CONARE. La expositora por parte de LANOTEC fue la investigadora Rebeca Corrales.

26


Sphingolipid-based synergistic interactions to enhance chemosensitivity in lung cancer cells
Charla impartida por la investigadora Susana Mesén durante el evento internacional “Sphingolipid Biology: the dawn of a new era” en Portugal. El evento fue organizado por FEBS.
Nanoformulaciones de productos naturales: curcuminoides de Curcuma longa y proantocianidinas de Uncraria tomentosa

La sociedad Química del Perú y SILAE organizaron el XXX Congreso Peruano de Química y XXX Congreso Italo-Latinoamericano de Etnomedicina, dinde el 18 de octubre de 2023, la investigadora Andrea Araya impartió, de manera presencial, la charla Nanoformulaciones de productos naturales: curcuminoides de Curcuma longa y proantocianidinas de Uncraria tomentosa
Generation and Applications of Aluminum-Based Nanostructures: from Antibacterial Surfaces to Plasmonic Substrates
El 20 de octubre el investigador Sergio Paniagua impartió la charla citada anteriormente, durante la Conferencia del Caribe sobre Materiales Funcionales CARIBMAT 2023, en Puerto Rico. El evento fue presencial.
27




CNCA
Evaluation of Alternatives to Accelerate Scientific Numerical Calculations on Graphics Processing Units using Python, por el investigador Johansell Villalobos, en el evento “CARLA 2023 Latin America High Performance Computing Conference”.
Benchmarking AI-based plasmid annotation tools for antibiotic resistance genes mining from metagenome of the Virilla River, Costa Rica, por la investigadora Melany Calderón y Dorian Rojas Villalta, Kenia Barrantes, María Arias y Keilor Rojas, en el evento “5 IEEE International Conference on BioInspired Processing, BIP 2023”


Microvilli Semantic Segmentation in Microscopy Images Using a Visual Learning Pipeline, por el investigador Fabricio Quirós, en el evento 22nd IEEE International Conference on Machine Learning and Applications, ICMLA 2023. th


28

Expositor: Randall Loaiza Montoya,
CENIBiot
Max Chavarría Vargas
Simposio: I Simposio Costarricense en Microbiología Ambiental: de la Biodiversidad a la Biotecnología, San José,
Fecha: 23 de octubre de 2023
Charla: Digital Sequence Information (DSI) collaborations fo biodiscovery", durante las sesiones científicas llevadas a cabo durante la asamblea general de las Naciones Unidas (UNGA78)
Modalidad: Virtual
Fecha: 18 de setiembre
Expositor: Emanuel Araya Valverde
Charla: Latest research on the diversity of the tropical palm Acrocomia aculeata in Costa Rica and its potential for oil production, Universidad de Göttingen, Alemania.
Modalidad: Virtual.
Fecha: 25 de febrero de 2023
29
Gestión Ambiental


Prácticas de compras sostenibles dentro de la institución y nuestros hogares: Realizada por la investigadora Jazmín Calderón Quirós el 20 de noviembre del 2023. Lugar CONARE por zoom.
Simposio de primatología XI: Dispersión de semillas por (Alouatta palliatta) en hábitats severamente alterados, Santa Cruz, Guanacaste, Costa Rica: Realizada por la investigadora Jazmín Calderón Quirós el 22 de noviembre del 2023. Lugar Panamá por zoom.
Taller de aguas residuales: "Un impacto al medio ambiente": Realizada por la investigadora Jazmín Calderón Quirós el 28 de noviembre 2023. Lugar CeNAT/CONARE por zoom.
Taller: Acciones dentro de la institución para hacer frente a las amenazas climáticas: Realizada por la investigadora Jazmín Calderón Quirós el 29 de noviembre del 2023. Lugar CONARE.
Charla de gases refrigerantes “Una simple acción para un gran impacto”: Realizada por la investigadora Jazmín Calderón Quirós el 29 de noviembre del 2023. Lugar CeNAT/CONARE por zoom.
Charla “Una apertura a la gestión de los residuos sólidos”: Realizada por la investigadora Jazmín Calderón Quirós, el 11 de diciembre 2023. Lugar CONARE.
Taller de expresión y gastronomía “El pejibaye en tus manos”: Realizado por la coordinadora del programa de Agromática, Seguridad Alimentaria y Slow Food, Patricia Sánchez Trejos, el 17 de junio 2023. Lugar Museo Nacional.


30
PRIAS
Experiencias de aprendizaje ambiental-geoespacial dentro del marco de acción del Laboratorio PRIAS e información geoespacial al servicio de los ciudadanos: La investigadora Heileen Aguilar y analista de infraestructura Stephanie Leitón, presentaron el tema Experiencias de aprendizaje ambiental-geoespacial dentro del marco de acción del Laboratorio PRIAS en el Simposio Virtual de Experiencias de Educación Ambiental, realizado el 28 de septiembre de 2023.
Charla magistral sobre el quehacer del laboratorio PRIAS: PRIAS 20 años construyendo investigación geoespacial: El 27 de noviembre de 2023 se llevó a cabo el evento PRIAS 20 años de Investigación Geoespacial, como parte de este la directora, Cornelia Miller brindó una charla magistral sobre el quehacer del laboratorio y la investigadora Heileen Aguilar brindó las palabras de cierre acerca de los compromisos y próximas metas que estará llevando a cabo el PRIAS.
Charla sobre el proyecto MONEO-WET: El 02 de mayo de 2023, el investigador Iván Ávila llevó a cabo una charla magistral a estudiantes de la escuela de Ingeniería Ambiental del Instituto Tecnológico de Costa Rica sobre el proyecto MONEO-WET en el segmento "Charlas al medio día" que organiza la escuela, lo acompañó la investigadora Heileen Aguilar y en conjunto además se promocionó el programa de Becas CeNAT-CONARE.
PRIAS 20 años construyendo investigación geoespacial: En el mes de diciembre de 2023, la directora Cornelia Miller participó como invitada a la primera sesión Latin Women in Space con una presentación sobre los 20 años del PRIAS construyendo investigación geoespacial y su papel como mujer lideresa en las áreas STEM con un enfoque en las observaciones de la tierra.


31
Programa de Becas
CeNAT –CONARE

Por iniciativa de los Rectores de las universidades integrantes del CONARE, desde el año 2013 se abre el programa de becas para incentivar a estudiantes a que desarrollen trabajos finales de graduación o investigaciones, inscritas en las universidades estatales, vinculadas con las áreas propias del CeNAT.
Los objetivos y temáticas de estas investigaciones y trabajos de graduación deben vincularse directamente con los temas de competencia del LANOTEC, CNCA, CENIBiot, PRIAS y Gestión Ambiental según concursos específicos que se abren en las universidades públicas, que son divulgados por los medios de comunicación institucionales y por las Vicerrectorías de Investigación de cada universidad.
Durante el año 2023, a solicitud de la Universidad Estatal a Distancia (UNED), se ajustaron las fechas del concurso para que se acoplen a los ciclos lectivos propios de ésta, de manera que el concurso de becas 2023 inició el 28 noviembre del 2022 y se extendió hasta agosto de 2023, de manera que iniciaron en setiembre de 2023 y están proyectadas para concluir en junio del 2024.
Un hito importante fue la celebración de los primeros 10 años del Programa de Becas CeNAT/CONARE, en cuyo marco se elaboró una memoria de las becas desarrolladas durante los últimos 10 años; además, se realizó una presentación de pósters de las becas 2022-23 y un acto protocolario de alto nivel el 22 de agosto, 2023.
32

Con la intención de evitar traslape de becas e ir ajustando calendarios, el concurso 2024-25 inició el 10 de diciembre, 2023 para concluir todo el proceso en junio de 2024 y con la expectativa de iniciar las nuevas becas en julio de 2024.
Para la estrategia de promoción de las becas, se generaron cinco afiches diferentes de promoción, según afinidad con los diferentes laboratorios, y se reutilizaron los cuatro videos promocionales desarrollados el año anterior. A continuación, se despliegan los afiches:












33
Becas asignadas (por universidad y laboratorio por año) del 2018 al 2023
Fuente: Información del año 2023, proporcionada por los Laboratorios y Área del CeNAT.

UCR UNA UNED ITCR UTN TOTAL / LAB UNIVERSIDAD
BECAS CeNAT-CONARE 2018-2023 CANTIDAD - UNIVERSIDAD - LABORATORIO LANOTEC CENIBIOT GESTIÓN AMBIENTAL CNCA PRIAS TOTAL / Universidad 3 2 0 1 0 6 1 0 0 2 0 3 2018 5 1 0 2 0 8 2019 7 0 1 1 0 9 2020 1 0 0 3 0 4 5 0 0 1 0 6 2018 2 1 0 0 0 3 2019 2 0 0 2 0 4 2020 1 1 0 0 0 2 1 1 2 0 0 4 2018 0 0 1 1 0 2 2019 1 0 1 0 0 2 2020 5 1 0 1 0 7 4 0 0 0 0 4 2018 4 0 0 1 0 5 2019 2 1 0 0 0 3 2020 6 0 0 1 0 7 2021 2022 2 1 0 0 0 3 2021 2022 2 0 0 0 0 2 2021 2022 2 0 0 1 0 3 2021 2022 0 2 0 1 0 3 1 1 1 2 0 5 2018 0 0 0 1 0 1 2019 2 0 0 3 0 5 2020 3 1 0 2 0 6 2021 2022
1
TABLA
10 6 0 6 0 22 12 2 3 5 0 22 2018 11 2 1 5 0 19 2019 14 1 2 6 0 23 2020 2021 15 2 0 4 0 21 2022 2023 5 1 1 0 0 7 3 2 0 1 0 6 2023 2 0 0 1 0 3 2023 2 0 0 2 0 4 2023 1 0 1 0 0 2 2023 27 4 2 7 0 40 Subtotal 20 5 0 3 0 28 Subtotal 7 2 4 3 0 16 Subtotal 14 1 0 8 0 23 Subtotal 7 4 2 9 0 22 Subtotal 13 3 2 4 0 22 2023 Cantidad total de becas CeNAT-CONARE 2018 al 2023 por laboratorio y área LANOTEC 40 CENIBiot 28 Gestión Ambiental 16 CNCA 23 PRIAS 22 34
ASIGNACIÓN DE BECAS 2013 - 2023

Fuente: Información del año 2023, proporcionada por los Laboratorios y Área del CeNAT.
TABLA 2
Individualización de las Becas asignadas para el año 2023

Adolfo Enrique Piedra Mora
Brayan Rodriguez Delgado
David José Araya Gutiérrez
Dilan Rojas Saborío
Dorian Rojas-Villalta
Esteban Bertsch Aguilar


INDIVIDUALIZACIÓN DE BECAS ASIGNADAS
Desarrollo de un modelo tridimensional paramétrico del patrimonio histórico arquitectónico la Ermita de la Agonía de Liberia con metodología HBIM utilizando escaneo láser tridimensional
Implementación de un algoritmo de aprendizaje automatizado para la detección de áreas quemadas con imágenes satelitales en Costa Rica
Diversidad genética del árbol Hevea brasiliensis (Willd. Ex A. Juss) para el cultivo comercial en Costa Rica
Membranas de colágeno reforzadas con nanofibras naturales obtenidas de biomasa para la regeneración guiada de tejidos
Bioprospección genómica y funcional de nuevas moléculas con potencial antibiótico en nuevas cepas de microorganismos extremófilos de la Antártica
Creación y Evaluación de Modelos Computacionales para la Predicción de Lipofilicidad en Carbohidratos
UCR UNA UNED TEC UTN TOTAL / LAB UNIVERSIDAD
No. Estudiante Propuesta Universidad Área/Laboratorio 1 2 3 4 5 6
UCR UNED TEC UNA TEC UCR PRIAS PRIAS CENIBiot CENIBiot CNCA CNCA
CNCA 29 1 1 10 0 41 CENIBiot 30 17 0 12 0 59 LANOTEC 35 10 2 11 0 58 PRIAS 8 10 4 15 0 37 Total / Universidad Gestión Ambiental 8 6 5 4 0 23 110 44 12 52 0 218
35

INDIVIDUALIZACIÓN DE BECAS ASIGNADAS
No. Estudiante Propuesta Universidad Área/Laboratorio
Geisel Cabrera Lazo
Isaura Gutiérrez Vargas
Javier Stuardo Chinchilla Orrego
Johana Valera Rangel
Jordan Hernández Ledezma

Julián Sánchez Castro
Karen Andrea Salazar Barrantes
Prototipo de encapsulamiento de Trichoderma sp. con matrices poliméricas para combate de Fusarium sp. en el cultivo de papaya
Machine Learning para el pronóstico de caudales mínimos en la vertiente pacífica de Costa Rica
Análisis del proceso y calidad del compost sintético y artesanal (Takakura) obtenido de la degradación de PLA de (40 μm) utilizado para el empaque de alimentos

Caracterización de metabolitos con actividad antifúngica producidos por actinomicetos del género Pseudonocardia

Laura Rojas Artavia
Lucía Noboa Jiménez
UNA
UCR UCR

UCR
CENIBiot
CNCA
LANOTEC
CENIBiot
“Novo café próspera: desempeño morfo-fisiológico y molecular de mutantes candidatos M3 de café (Coffea arabica L cv. Catuaí) en respuesta a la “roya anaranjada” (Hemileia vastatrix) y el incremento de temperatura”
Simulación del campo magnético del stellarator SCR-1 para el cálculo de la velocidad radial y visualización del mapa vectorial de campo en flujo turbulento
Atorvastatina cálcica trihidratada: caracterización del estado sólido, estudio de compatibilidad y efecto del proceso de producción de comprimidos en su estabilidad polimórfica
Andamio de Nanofibras de Ácido Poliláctico Impregnados de Deflazacort con Técnica Air Jet Spinning
Cambios ultraestructurales y de patrones de expresión génica inducidos por Trichoderma rifaii en
UNED TEC UCR UCR UCR
LANOTEC CNCA

LANOTEC
LANOTEC
CENIBiot

LANOTEC

7 8 9 10 11 12 13 14 15
36
Vanessa Morales Cerdas
Andrea Rivera Álvarez (Extensión)
Fiorella Calderón (Extensión)
INDIVIDUALIZACIÓN DE BECAS ASIGNADAS
Determinación experimental de las variables significativas de un proceso de granulación en un equipo de lecho fluidizado y un proceso de recubrimiento en un equipo de bombo perforado del Instituto de Investigaciones Farmacéuticas (INIFAR) para la fabricación de tabletas recubiertas
Diversidad y estructura genética del coral Pocillopora spp en dos sitios del Pacífico Tropical Oriental
Evaluación del mejoramiento de señal Raman de rodamina 6G en capas de oro con nanotopografías de discos ópticos comerciales, por medio de espectroscopía SERS
Flexibilidad dietética de los monos aulladores (Alouatta palliata palliata) en hábitats alterados en Santa Cruz, Guanacaste: implicaciones para la sostenibilidad y conservación
Desarrollo de sistema de alimentación limpia, fotovoltáica y eólica, de periféricos (computadoras, refrigeradora, compresor, otros) de laboratorio móvil prototipo eléctrico Misión Antártida 2022 - 25
Diseño de un centro de Investigación móvil Prototipo alimentado Con energías limpias para La expedición científica a Antártida en enero 2022-2025
LANOTEC CENIBiot
AMBIENTAL
GESTIÓN AMBIENTAL
GESTIÓN AMBIENTAL


Resumen
Todas las propuestas aprobadas tienen un alto impacto tanto en la generación de nuevos conocimientos (a través de artículos, trabajos de graduación, generación de nuevos productos, otros), en temas relacionados con energías limpias, generación de nuevos productos, prevención de desastres naturales, entre otros, a lo largo de estos 10 años.
Además, el resultado cuantitativamente hablando demuestra una muy buena gestión y proyecciones promisorias a futuro, gracias a la gran capacidad de adaptación y resiliencia del Programa.
No. Estudiante Propuesta Universidad Área/Laboratorio 17 18 19 20 21 22 Michael Solano Rojas Randall Vinicio Hidalgo Sánchez
Moya Salas
Sebastián
UCR UCR UCR UCR TEC
UCR
LANOTEC GESTIÓN
37

LANOTEC



Publicaciones científicasPúblico Privado Total 27 6 33 Actividades de transferencia 33 7 40 18 18 36 3 1 4 55 9 64 Plan Anual Operativo LANOTEC (CeNAT-CONARE) 2023 DISTRIBUCIÓN DE LAS METAS ALCANZADAS INDICADORES 39
INTRODUCCIÓN
El Laboratorio Nacional de Nanotecnología (LANOTEC) del Centro Nacional de Alta Tecnología (CeNAT); se creó el 4 de agosto del 2004, inició desarrollando investigación con la meta de ser líder tecnológico en la región centroamericana y de El Caribe, con ingeniería de punta en el estudio de materiales avanzados para la investigación, diseño y entrenamiento en tecnologías asociadas a la microtecnología, nanotecnología y ciencia de los materiales.
Se especializa en el estudio de materiales, desarrollo de investigación científica y generar conocimiento desde las diversas áreas que trabajan en sinergia para el desarrollo de avances en la ciencia, permitiendo colaborar con la


Cuenta con áreas establecidas, sin embargo, predominan: investigación científica, innovación-emprendedurismo, así como docencia y extensión.
tecnologías que permitan el mejoramiento de productos y procesos en el sector industrial, y coadyuven a disminuir la brecha de la nanotecnología entre los países desarrollados y pobres; esto con la formación y apoyo de un comité científico, la Dirección del CeNAT y la Dirección del Laboratorio marcan el norte del laboratorio y el rumbo que se debe seguir en las investigaciones científicas
40
Objetivo desarrollode
Generar valor científico desde la nanobiotecnología a iniciativas de innovación de procesos y productos que impactan el desarrollo económico de Costa Rica.

Misión

Visión
Somos un centro de investigación de aprovechamiento en nanobiotecnología que cuenta con profesionales especializados que realizan estudios con los más altos estándares científicos en el marco de innovación y el desarrollo para el sector público, privado y social de la Región.
Ser un centro de investigación autosostenible de alto impacto económico a nivel nacional e internacional, que aporta en la generación del conocimiento en materia de nanobiotecnología, siendo líder en el fortalecimiento del desarrollo competitivo y la articulación intersectorial.
41


Áreas de desarrollo estratégico del LANOTEC
Valores
Gestión colaborativa en los proyectos que se emprenden
Socialización de la información científica
Gestión de proyectos responsable
Compromiso con los procesos y productos que se emprenden
Principios
Uso eficiente de los tiempos
Uso eficiente de la infraestructura tecnológica
Sana gestión administrativa de los proyectos de investigación
Generación de ideas para mejoras de procesos
Ciencias de la vida
Innovación y desarrollo
Regulaciones y normativa Vocaciones Científicas
42
Objetivos



Nodos estratégicos

Extensión y docencia
Innovación y emprendimiento
Investigación científica
Innovación y emprendimiento Acreditación ISO 17025
Investigación científica
Extensión y docencia
Arte (Nanoarte, arte conceptual y deporte)
Arte (Nanoarte, arte conceptual y deporte)
17025
43




















Indicadores
Q1 Q2 Q3 Q4 Especializada Indexada SCIMAGO Scopus Indexado en otros índices Total 13 3 1 15 4 27 2 1-2 1 6 15 4 1 17 5 33 Detalle de las publicaciones: Clasificación Públicas Privadas Total Otras indexadas
TOTAL 33 29 4 Indexadas en Scopus 44
Impacto
PUBLICACIONES





























































































CONOCIMIENTO TRANSFERENCIAS DE TOTAL 40 35 Nacionales Personas beneficiadas: Talleres Cursos, simposios 5 Internacionales Talleres Cursos, simposios 1.038 45

Proyectos de investigación TOTAL 36 18 Públicos FEES Fondos CONARE Internos (LANOTEC OPERATIVO) 2 3 13 TOTAL 64 Becas Acompañamiento de tesis – Trabajo final de gradación, Pasantía y Voluntariado Horas asistente 15 37 12 18 Privados Otros Fondos Públicos Fondos Privados Proyectos en negociación Dos Pinos Coopeatenas 4 14 Vinculación a nivel nacional Vinculación a nivel internacional 9 3 Atención de estudiantes 46
Articulaciones




Sector académico nacional:
Universidad de Costa Rica
Universidad Nacional
Instituto Tecnológico de Costa Rica, Universidad Técnica Nacional, Universidad Estatal a Distancia
Universidad Invenio
ULACIT, ULatina de Costa Rica
Universidades o institutos internacionales:
Universidad de la República Uruguay
Universidad Privada del Norte, Perú
Instituto Max Planck, Alemania
Universidad de Belgrado, Serbia
Universidad de Buenos Aires, Argentina
Universidad de París, La Sorbona
Empresas internacionales:
Phillips Morris Confluent Medical Boston Scientific Allergan Smith Interconnect
Proquinal CooperVisión Establishment Lab Ilsi Mesoamérica
Empresas nacionales:
Laboratorios Stein Laboratorios Calox Laboratorios Lisan Florida Ice & Farm Corp.
Asoproa Ecoinsumos
47





Convenios TOTAL 4 Nacionales Internacionales 3 1 48




PROYECTOS FEES
Descripción general Proyecto
Papel de los neutrófilos y el complemento en la modulación de la respuesta Inmunológica contra infecciones bacterianas de importancia en Costa Rica
Obtención de películas biodegradables con actividad antimicrobiana a partir de residuos agroindustriales y marinos
PROYECTOS FONDOS CONARE
Resumen de Proyectos


Este proyecto permite generar información científica de tipo básico sobre la patogénesis y biología de estas bacterias. Favorece la colaboración interuniversitaria y la formación de nuevos investigadores y mejora el entendimiento general de dos infecciones bacterianas de alta importancia en salud pública animal y humana en el ámbito nacional.
El objetivo de esta propuesta es desarrollar películas de quitosano biodegradables, con actividad antimicrobiana, a partir de residuos agroindustriales y marinos.
Descripción general Proyecto
LANOTEC Operación.
Olimpiadas Costarricenses de Química y Ciencias.
Max Planck: Understanding of the velvet worm anti-adhesive skin mechanism as a model for biodegradable and low protein adsorption coatings.
Impulsar el desarrollo científico en la Región a través del trabajo colaborativo entre el equipo de investigadores del LANOTEC y estudiantes, enfocándose en la ejecución de proyectos, la publicación de resultados, la creación de convenios y la transferencia de conocimiento. El propósito es generar un impacto significativo en los sectores público, privado y social, contribuyendo al avance y fortalecimiento de la región.
El propósito de este proyecto es fomentar las vocaciones científicas y la gestión ambiental, en las personas estudiantes que participan en las Olimpiadas Costarricenses de Ciencias y Química, dentro del marco general de los ODES.
Este proyecto tiene como objetivo generar conocimientos fundamentales sobre las propiedades antiadherentes de la piel del gusano de terciopelo y sus mecanismos para diseñar recubrimientos antiadherentes sostenibles, dentro del concepto del biomimetismo.
1
1 2 3 2
49

PROYECTOS LANOTEC OPERACIÓN (PROYECTOS INTERNOS)
CSIC Arsenic-free - new nano-structured multifunctional materials to remove arsenic in groundwater


ARSENIC-FREE propone contribuir al desarrollo humano a través de la implementación de un desarrollo colaborativo internacional y con base científico-tecnológica. El desarrollo consiste en la fabricación, caracterización y escalado de una membrana compuesta por nanofibras electrohiladas que contienen nano-partículas con alto poder de captación de As. Debido al mecanismo de adsorción y a su bajo costo, la membrana no requiere de energía eléctrica para actuar y por lo tanto puede ser utilizada tanto en centros urbanos desarrollados como en comunidades vulnerables sin acceso a energía eléctrica o agua segura

Elucidación estructural de la forma A del irbesartán utilizando los métodos de Rietveld y Le Bail
Desarrollo e implementación de herramientas para el entendimiento de la nanotecnología desde la práctica: haciendo visible lo invisible 2021-2023


Se está trabajando en colaboración con el Laboratorio de Cristalografía Aplicada de la Universidad General San Martín de Argentina. Se han utilizado datos experimentales de difracción de rayos-X de polvo del irbesartán forma A. Se han aplicado los métodos de Rietveld y Le Bail a estos datos utilizando el software FullProf Suite. No se han obtenido resultados muy prometedores, por lo que se está trabajando en los cálculos determinados manualmente de todas las reflexiones hkl de la estructura basándose en la ficha de esta estructura reportada en el PDF4/Organics.
El objetivo es capacitar a educadores y adolescentes en bionanotecnología mediante charlas y prácticas utilizando un lenguaje de fácil entendimiento. Proyecto Bilateral Costa Rica-Uruguay. Se desarrollaron los talleres programados sobre la divulgación de nanotecnología, tanto en Costa Rica como en Uruguay.

Adicionalmente se realizaron las respectivas grabaciones para la edición de los videos relacionados a la parte experimental relativa a la nanobiotecnología



Descripción general Proyecto
1 2 3
50

Polimorfismo cristalino en nanomateriales y sistemas blandos: aspectos básicos y relevancia tecnológica
Identificación de las proteínas de la membrana basal vascular y matriz extracelular circundante a las que se unen las metaloproteinasas de venenos de serpiente por medio de estudios de inmunomicroscopía electrónica
Desarrollo de prototipo de un dispositivo médico que permita el abordaje de patologías neurológicas mínimamente invasivas
Efecto del proceso de producción de comprimidos en la estabilidad polimórfica de la atorvastina cálcica trihidratada
Este es un proyecto macro que aborda varias temáticas, el LANOTEC participa específicamente en la línea “Polimorfismo en compuestos de interés farmacéutico: influencia del tamaño de cristalita”, cuyo objetivo es estudiar la influencia del tamaño de cristalita en la retención de los polimorfos más adecuados de las moléculas seleccionadas (saquinavir y la curcumina) por su biodisponibilidad. Se considerarán procesos de reducción del tamaño de cristal con equipamiento disponible en la industria farmacéutica. De acuerdo llos resultados obtenidos se podrán extender a otras moléculas de interés farmacológico
Estudiar la distribución y colocalización de diferentes tipos de metaloproteinasas hemorrágicas de venenos de serpiente con proteínas de la membrana basal vascular y matriz extracelular circundante en tejido muscular murino por medio de pruebas de inmunomicroscopía electrónica con el fin de identificar el componente al que se unen estas toxinas
El objetivo de este proyecto es desarrollar mecanismos y artefactos de acceso mínimamente invasivos que faciliten el desarrollo de operaciones neurológicas complejas, mediante el empleo de impresión 3D del FabLab del LANOTEC, en conjunto con el Dr. Miguel Esquivel del Hospital México.
Caracterizar la materia prima de la atorvastatina cálcica trihidratada (ATC) y evaluar el impacto de los procesos de manufactura en su estabilidad polimórfica, incluyendo el análisis de las interacciones fármaco-excipiente como parte integral de estudios de preformulación. El propósito es garantizar la calidad y seguridad del producto final al comprender y controlar los aspectos polimórficos durante la formulación de la ATC, contribuyendo así a la optimización de su proceso de manufactura
Desarrollo de nanopartículas acarreadoras de polifenoles naturales para controlar la contaminación de granos por micotoxinas
Desarrollar y evaluar la eficacia de nanopartículas (NPs) poliméricas que encapsulan polifenoles extraídos de plantas de Costa Rica, con el fin de controlar las micotoxinas en granos como maíz, frijol, arroz y maní. Este proyecto también tiene como objetivo proporcionar una alternativa viable para pequeños productores al abordar la limitada estabilidad y solubilidad de los polifenoles, y al mismo tiempo, garantizar la inocuidad de los granos almacenados en condiciones comunes utilizadas por estos productores en Costa Rica
8 7 Descripción general Proyecto
4 5 6
51
PROYECTOS LANOTEC OPERACIÓN (PROYECTOS INTERNOS)
Proyecto
Interacción de nanopartículas de óxidos metálicos de relevancia en los suelos con iones fosfato y materia orgánica


Descripción general
Comparar la reactividad de tres nanopartículas minerales de óxidos de hierro y aluminio (ferrihidrita, nano-Al(OH)3 y alófana) en relación con la retención de fosfato y materia orgánica del suelo (MOS). Utilizar experimentos de adsorción en sistemas modelo y técnicas de microscopia electrónica y espectroscopia para caracterizar las interacciones a nivel micro y nanoscópico. El propósito es generar conocimiento fundamental para comprender la reactividad de las NPox en suelos, estableciendo las bases para investigaciones futuras sobre su impacto en funciones ecosistémicas esenciales, como el suministro de nutrientes y el almacenamiento de carbono orgánico, en suelos de Costa Rica

Evaluación del potencial de sensores fluorescentes análogos a esfingomielina para identificar mecanismo de interacciones quimioterapéuticas en células cancerígenas

Seguridad, sostenibilidad y resiliencia en sistemas de aprovechamiento de biogás escala doméstica y pequeña en el sector agropecuario y agroindustrial


Analizar el metabolismo de esfingolípidos y las interacciones quimioterapéuticas en un modelo de cáncer de pulmón utilizando la línea celular A549 cargada con un análogo fluorescente de esfingolípidos (SM-BODIPY). Se pretende investigar las interacciones citotóxicas entre las drogas quimioterapéuticas convencionales (epirrubicina, cisplatino y paclitaxel) y perturbaciones en la vía de esfingolípidos (inhibidores enzimáticos) o moduladores de autofagia (activadores o inhibidores) mediante microscopía de fluorescencia. El objetivo final es mejorar la comprensión de las respuestas celulares ante tratamientos, con implicaciones potenciales para el desarrollo de estrategias terapéuticas más efectivas contra el cáncer de pulmón

Desarrollar un proyecto integral para tecnificar los sistemas de biodigestión anaerobia en Costa Rica, con énfasis en la mejora de la seguridad y eficiencia en la producción de biogás. Se pretende analizar y mitigar los riesgos asociados, aplicando la Ciencia de Materiales para la purificación del metano y la utilización de materiales nanoestructurados como carbón activado, óxido de grafeno y suelos arcillosos con óxidos de hierro. El LANOTEC aportará con su experiencia en biorefinación y desarrollo de nanotecnología para filtros. El objetivo final es implementar un plan piloto en la región Caribe, capacitando a beneficiarios en el manejo seguro y sostenible del biogás, e instalando filtros para mejorar la seguridad y eficiencia de los sistemas de biodigestión


OPERACIÓN
INTERNOS) 9 11 10 52
PROYECTOS LANOTEC
(PROYECTOS
PROYECTOS LANOTEC OPERACIÓN (PROYECTOS INTERNOS)
Proyecto
Fabricación de celdas biosolares a partir de biomasa de microalgas: Doble cosecha de la energía solar para producción de proteínas fotosintéticas y energía fotovoltaica
Biosensor microfluídico para detección de Brucella abortus: prueba de concepto para detección de agentes infecciosos bajo estándares de la OMS.
Descripción general
Desarrollar celdas biosolares basadas en biomasa renovable y organismos fotosintéticos para captura eficiente de energía solar. Utilizar nanotecnología para mejorar la eficiencia y superar limitaciones en la transferencia de carga en los electrodos. Implementar un cultivo de microalgas en el TEC bajo condiciones naturales específicas para la producción de proteínas y extracción de pigmentos esenciales para la construcción de las celdas biosolares. Avanzar el conocimiento en Costa Rica para aprovechar estos recursos biológicos y aplicarlos en dispositivos con alto valor agregado, contribuyendo así al desarrollo de tecnologías más sostenibles y eficientes en la captura de energía solar
Mejorar un dispositivo microfluídico existente para convertirlo en un biosensor de afinidad que permita la detección específica de bacterias en fluidos biológicos en 30 minutos. Introducir aptámeros de ADN para asegurar la especificidad de la detección. Evaluar la eficiencia del

Proyecto Tarjetas de Crédito BAC (Tarjetas BAC)
Evaluar muestras de tarjetas de crédito y/o débito de la empresa BAC conformadas por 2 polímeros comerciales. Tuvo una excelente cobertura mediática
1 2 12 13 53
Descripción general Proyecto
Fomento de vocaciones científicas Feria Challenge (Challenge ISEF)

H2020 – Automated functional screening of IgGs for diagnostics of neurodegenerative diseases (AUTOIgG)
Evaluación de PLA para la fabricación ecosostenible de envases. (FIFCO)
Evaluación del impacto del humo de un cigarrillo vs THS en la calidad del aire interno. (PMI Calidad de Aire)
Evaluación de las características fisicoquímicas del abacá producido en la zona de Horquetas de Sarapiquí y el desarrollo de una metodología de purificación de las fibras obtenidas por el proceso costarricense de extracción. Proyecto fibra de abacá. (Nippon Paper)
Diseño y desarrollo de un modelo de concepto para establecer un estudio bioinformático de cáncer de pulmón por medio de visión artificial de las imágenes 3D de escala nanomolecular y biomarcadores moleculares circulantes de genes asociados. (Cáncer de Pulmón)
Evaluación de la actividad antimicrobiana de telas vinílicas producidas por la empresa Proquinal Proyecto Argento Fase II
Incentivar un acercamiento con los centros académicos del país y dar apoyo en el desarrollo de eventos a nivel científico (ferias), con el fin de incentivar el desarrollo de vocaciones científicas a nivel país. Este proyecto depende del interés de los organizadores de las Ferias Científicas y de Tecnología, así como la de Ingeniería nacionales
Implica el desarrollo de modelos celulares experimentales y procedimientos con inmunoglobulinas (IgGs) de sueros de pacientes como tecnologías de diagnóstico y pronóstico relacionadas con enfermedades neurodegenerativas, ND (particularmente basado en la esclerosis lateral amiotrófica - investigación ALS). Además, la definición de las características de marcado del enfoque in vitro estandarizado para Protocolos de diagnóstico de los ND, y el diseño de una plataforma a pequeña escala basada en microscopía de fluorescencia automatizada
Investigar materiales alternativos al plástico y procesos de compostaje para reducir el impacto ambiental
Se evaluó la afectación a la calidad del aire en un espacio al aire libre, producido por el humo emitido al fumar cigarrillos convencionales contra el aerosol generado por dispositivo THS
El proyecto tiene como objetivo principal evaluar las características morfológicas y de contenido de sílice presentes en el abacá de Costa Rica. Además, comparar con los datos reportados para los cultivos de Filipinas y Ecuador y determinar si el contenido de sílice es mayor que el reportado en otros países; con el fin de identificar si hay una variación significativa que pueda justificar un proceso de remoción parcial. Se plantea estudiar la estructura de la planta interna y externa tanto de madura como verde para entender sus diferencias morfológicas y fisicoquímicas
Diseñar y desarrollar un modelo de concepto que establezca un estudio bioinformático de cáncer de pulmón mediante la aplicación de visión artificial en imágenes 3D de escala nanomolecular, integrando biomarcadores moleculares circulantes de genes asociados. Este enfoque busca mejorar la comprensión y análisis de la enfermedad, permitiendo una evaluación detallada de la nanomorfología y la presencia de biomarcadores moleculares circulantes para una mejor caracterización y diagnóstico del cáncer de pulmón
En este proyecto se tiene como objetivo principal el evaluar las características antimicrobianas de telas vinílicas en términos de adhesión bacteriana y actividad antimicrobiana de dos tipos de telas LACA PH y LACA Spectra. Para esto se evaluará la morfología y rugosidad usando el AFM y SEM. Además, se realizarán los ensayos microbiológicos usando dos bacterias una bacteria Gram - y Gram + siguiendo el método prueba JIS Z 2801,44. Se seguirán los protocolos utilizados en la fase I
PROYECTOS FONDOS PRIVADOS 3 4 5 6 7 8 9 54
Desarrollo de un sistema sensor para la determinación rápida de biomoléculas. (Proyecto Panamá)
Prototipo de Biopolímeros, obtenidos a partir de residuos biomásicos piñeros. (BIO TAG)
Nanopartículas de metales biosíntetizadas a partir de residuos agroindustriales aplicadas en la funcionalización de bioplásticos para uso en la cadena industrial de berries
Alternatives for interface-modified and 2D/3D perovskite absorbers for perovskite solar cell application. (NAVAL)
Descripción general
Desarrollar un sistema sensor con el propósito de lograr la determinación rápida de biomoléculas
Crear un prototipo de biopolímeros utilizando residuos biomásicos provenientes de la industria piñera
Desarrollar nanopartículas de metales mediante síntesis biológica utilizando residuos agroindustriales y aplicarlas en la funcionalización de bioplásticos destinados al uso en la cadena industrial de berries
Desarrollar y optimizar células solares de perovskita mediante la síntesis, caracterización y aplicación de perovskitas mixtas 3D-2D. Diseñar, sintetizar y evaluar arilaminas sustituidas coordinadas por germanio como transportadores de huecos (HTL) en estas células solares. Investigar el impacto del uso de ácidos fosfónicos y puntos cuánticos de carbono como modificadores de superficie y capas interfaciales en el rendimiento y estabilidad de las células solares de perovskita, mediante la correlación con propiedades como la energía de superficie, cambios en la función de trabajo local, morfología de la capa activa, cristalinidad y absorbancia, utilizando técnicas como microscopía de fuerza con sonda Kelvin
Programa Desarrollo prototipos de Biomateriales 2023 (CINDE – INA).
Brindar el apoyo técnico necesario a pequeñas empresas para impulsar el desarrollo de 10 prototipos de productos.

PROYECTOS FONDOS PRIVADOS 10 11 12 13 14 55
Proyecto

OTROS FONDOS PÚBLICOS

Descripción general Proyecto
FI-55B-19: Revalorización de la broza del café como material adsorbente alternativo al carbón activado en la remoción del bromacil de fuentes agua
FI-0006-20: Nano-fitofármacos para la prevención y el tratamiento de COVID-19: Escalamiento de nanosistemas sólido-lipídicos y estudio in silico e in vitro de candidatos inhibidores del virus SARS- CoV-2


Obtener nuevos materiales adsorbentes de bajo costo a partir de biomasa de café como alternativa al carbón activado en la remoción de bromacil de fuentes de agua
Este proyecto implica el escalar los procesos de nano-formulación solido-lipídicos de curcumina y piperina y sus materiales complejos para su aplicación a otras moléculas de origen natural con semejanza estructural, elucidadas a partir de estudios in silico e in vitro de inhibición del virus SARS-CoV-2 y tratamiento de COVID-19

PINN Queseros: Generación de capacidades agroindustriales y creación de una unidad integral (caracterización fisicoquímico, organoléptico y microbiológico) para el mejoramiento del proceso de producción del queso Turrialba con Denominación de Origen
FI-0002-2022 Terapia contra el cáncer mediante liberación micelar de fármacos a base de productos naturales costarricenses

Implica la generación de capacidades agroindustriales y creación de una unidad integral -un laboratorio de control de calidad para realizar análisis de caracterización fisicoquímico, organoléptico y microbiológico- para el mejoramiento del proceso de producción del queso Turrialba con Denominación de Origen
Desarrollar micelas inteligentes para la liberación de sustancias extraídas de la flora costarricense con potencial en el tratamiento del cáncer

1 2 3 4 56

CENIBiot










Privado Total 1 15 2 30 5 26 1 2 7 72 Plan Anual Operativo CENIBiot (CeNAT-CONARE) 2023 DISTRIBUCIÓN DE LAS METAS ALCANZADAS INDICADORES 58
INTRODUCCIÓN
El Centro Nacional de Innovaciones Biotecnológicas (CENIBiot) es un laboratorio interuniversitario de investigación, desarrollo, innovación y escalamiento en biotecnología adscrito al CeNAT y que cuenta con el apoyo financiero y supervisión del CONARE.
El CENIBiot contribuye a la generación de soluciones biotecnológicas innovadoras y la vinculación estratégica de los sectores académico, empresarial y gubernamental, mediante el apoyo a los emprendedores, la transferencia tecnológica y la vinculación universidad-empresa; y de esta forma lograr su visión de ser un “centro interuniversitario de clase mundial en innovación biotecnológica”.
El objetivo de desarrollo en CENIBiot es generar investigaciones biotecnológicas que aporten al crecimiento de Costa Rica, por medio
de proyectos científicos y de innovación de impacto, que contribuyan a la sociedad en el ámbito económico, social y ambiental, mediante el intercambio de cocimientos, servicios científicos y tecnológicos y alianzas con el sector empresarial.
El laboratorio promueve la internacionalización como estrategia para lograr competitividad, la captación de recursos externos y actualización constante. El modo de operación se basa en promover la apertura y accesibilidad a la capacidad instalada. Académicos, gestores de innovación, creadores de política pública y empresarios convergen en este crisol de innovación.
El presente informe tiene por objetivo presentar las principales acciones estratégicas desarrolladas por el CENIBiot (CeNAT-CONARE) en 2023, incluyendo las principales metas a partir de las acciones de apertura, vinculación e internacionalización planteadas en el Plan Estratégico 2019-2023 del CENIBiot y del CeNAT, así como la implementación y continuidad de las propuestas planteadas en:


El Plan de mejora e implementación del Plan Estratégico CENIBiot 2019-2023.
El Plan Estratégico 2024-2028 elaborado durante el 2023.
El Plan Nacional de la Educación Superior 2021-2025 (PLANES) de CONARE.
El Plan Nacional de Ciencia, Tecnología e Innovación 2022-2027 del Ministerio de Ciencia, Innovación, Tecnología y Telecomunicaciones (MICITT).
59
Acciones estratégicas ejecutadas en el año 2023
Durante el año 2023 CENIBiot continuó desarrollando líneas estratégicas que son la base de la producción científica y de las más relevantes alianzas con el sector productivo dentro y fuera de Costa Rica.
Con los fondos CENIBiot Operativo se favorecieron líneas estratégicas como el estudio de microorganismos, su biología, las interacciones biológicas en diversos ecosistemas y su aprovechamiento, principalmente en agricultura. Aproximadamente 75% de la producción científica se basa en estas temáticas. Gracias a estas fortalezas recibimos invitaciones para participar en prestigiosos espacios a nivel internacional organizados por instituciones como WIPO, WAITRO, Taller UNESCO-IEEE Emprendimiento, ACTIVA CATIE, entre otros. Se consolidó la participación en influyentes foros como el International Microbiology


Literacy Initiative (IMiLI) y se organizó un evento internacional en microbiología ambiental de gran nivel. Para seguir creciendo se invirtieron recursos significativos en desarrollar novedosas metodologías en metabolómica que a futuro se verán reflejadas en proyectos más robustos y de mayor impacto.
60
El prestigio, la confianza y visualización asociadas con las principales líneas de investigación favorecieron importantes colaboraciones con actores privados en Costa Rica y fuera de ella. Destacan la conclusión de la primera etapa del proyecto de I+D en colaboración con Mammoth Biosciences, de la Dra. Jennifer Doudna, premio nobel de química. Dio inicio el “Estudio de Diversidad Microbiana a Gran Escala en Costa Rica” con la empresa Basecamp Research de Reino Unido, que además permitió la donación de equipamiento de punta y entrenamiento para el ecosistema académico, generación de empleo y beneficios económicos para el sector privado. Gracias a esta alianza participamos de las sesiones científicas que se desarrollaron durante la Asamblea General de las Naciones Unidas (UNGA78) y la colaboración fue divulgada en medios de comunicación europeos. También, la empresa Compound-Foods basada en San Francisco-California confió en CENIBiot para acelerar el desarrollo de una línea estratégica de su plan de negocios. Finalmente, el liderazgo en el estudio de bioles para uso agrícola nos hizo merecedores de los fondos concursables del programa de cooperación triangular Adelante2 entre Latinoamérica y Europa dotado con más de $70 mil USD en materiales y logística.



En resumen, la perseverancia en líneas de investigación definidas estratégicamente empieza a dar los frutos esperados en la tarea de “transformar conocimiento en desarrollo” de la mano de los sectores productivos, adicionalmente al creciente reconocimiento y productividad académica que se ha experimentado por los últimos años.



61

Objetivo desarrollode


Misión
Generar investigaciones biotecnológicas que aporten al desarrollo de Costa Rica, por medio de proyectos científicos y de innovación de impacto, que contribuyan a la sociedad en el ámbito económico, social y ambiental, mediante el intercambio de cocimientos, los servicios en ciencia y alianzas con el sector empresarial.


Somos un laboratorio de investigación y desarrollo biotecnológico que trabaja con altos estándares científicos y donde convergen la educación superior de Costa Rica, el sector público y privado para acelerar la innovación de base científica y tecnológica.

Visión
Ser un laboratorio autosostenible de alto impacto científico, económico y social a nivel nacional e internacional que fortalece el desarrollo competitivo a través del rigor científico y la articulación intersectorial.



62
Valores presentes en el CENIBiot:
Cuidado de equipo humano.
Actitud de aprendizaje permanente.
Actitud de asombro por los hallazgos y logros obtenidos.
Gestión colaborativa en los proyectos que se emprenden.

Principios presentes en el CENIBiot:
Uso solidario y eficiente del equipamiento científico.
Sana gestión administrativa de los proyectos de investigación.
Disposición para una mejora constante de los proyectos que se emprenden.
Áreas de Desarrollo:
Biodiversidad / Biomoléculas Bioprocesos
Descubrimiento de fármacos
Comunidades microbianas
Agricultura sostenible
Innovación e impacto
63


Objetivos estratégicos



Generar soluciones basadas en insumos biológicos que permiten una agricultura ecológica con independencia tecnológica y mayor rentabilidad.
Comprender la composición y cinéticas de comunidades microbianas para estudios ecológicos de impacto ambiental y descubrimiento de drogas.



Ejecutar proyectos de investigación y desarrollo en bioprocesos para fortalecer el crecimiento científico regional y procesos de innovación.
Desarrollar proyectos de investigación y desarrollo que vinculen bioproductos con la evolución y prevención de desórdenes metabólicos y sus consecuencias.
Nodos estratégicos
Investigación en Bioprocesos.
Investigación en Descubrimiento de fármacos.
Investigación en Comunidades Microbianas.

Investigación en Agricultura Sostenible.
64
















Indicadores Impacto PUBLICACIONES 15 14 Indexadas 1 No Indexada Indexadas cuartil I Indexadas cuartil II 13 1 65












TOTAL 30 26 Nacionales (Impartidas) (Impartidas) 2 Internacionales Cursos, talleres, simposios 2 Fondos Privados CONOCIMIENTO TRANSFERENCIAS DE Personas beneficiadas: 194 66
Proyectos de investigación

Atención de estudiantes

TOTAL 72
Fondos públicos
Becas CeNAT: 9
Trabajos Finales de Graduación: 41
Horas estudiante, asistente y graduados: 15
Fondos Privados
Horas estudiante, asistente y graduados: 7
TOTAL 26 FEES Internos Fondos Promotora Costarricense: (Fondos incentivos) Fondos Privados 2 19 2 3
65 7
67


Articulaciones


Sector académico nacional:
UCR
UNA
TEC
UNED




Universidades e institutos nacionales e internacionales:
International Pharmacy
Students Federation (IPSF)
Universidad de Salamanca
Instituto tecnológico de Monterrey
Centro Nacional de Biotecnología de España
WAITRO
WIPO
CIRAD Francia CONARROZ
PROCOMER CATIE
Clúster de ciencias de vida Clúster biomateriales
Empresas internacionales:
Nippon Papper
Papylia CR
Boston Scientific
Thrive Natural Care
Cambrium
Mammoth
Biosciences
Compund-Foods
BaseCamp Research



Empresas nacionales:
Bio CR

BioTech CR S.A.
CoopeAgri R.L
CoopeCuna R.L.
CORBANA, S.A.
Corporación de Desarrollo Agrícola del Monte S.A
Establishment Labs S.A.
Granja Avícola Santa
Marta S.A.
Laboratorios Stein Speratum
Stein CORP.
BIOTECH
La Cotinga
Reserva Biológica
Tirimbina
Pelón de la Bajura

68

Nacionales
del
de
Rica” UCR- CENAT
Internacionales
Estudio de Diversidad Microbiana a Gran Escala en Costa Rica (Basecamp Research)
69
Convenios 1
FPP-CV-001-2023 “Búsqueda de bacterias productoras de antibióticos en la Caverna
Amblipigida
Costa
1
FP-CV-001-2023
TOTAL 2
Resumen de Proyectos




Descripción general Proyecto Fondos Públicos
FPP-FP-001-2023 Selección de microorganismos solubilizadores de fósforo con potencial bioestimulante en el crecimiento de plantas.
FPP-FP-002-2023 Contaminación del maíz costarricense por especies toxigénicas de Fusarium (FEES).
FPP-FP-003-2023 Efectos de hongos endófitos de aislados de plantas de la familia Rubiaceae en la morfología y la fisiología en plantas de café.
FPP-FP-004-2023 Papel de sorcin en la proliferación de linfocitos in vitro.
Se redujo el rango de concentraciones de trabajo para lograr una curva con linealidad aceptable para asignar un valor cuantificable para las muestras analizadas, está pendiente la evaluación final del ensayo de campo en café
Se ha realizado la secuenciación de las muestras. Además, se han depurado algunos pipelines para el análisis bioinformático y el análisis de los datos está en progreso.
Los resultados de este trabajo derivaron en un manuscrito que se encuentra publicado en la revista Journal of Applied Microbiology, por lo que este se encuentra finalizado.
Como resultado del proyecto fue enviado el manuscrito para revisión a la revista Biology Methods and Protocols; sin embargo, esta fue rechazada, actualmente se procede a someter en la revista Analytical Biochemistry.
Se avanzó en la planificación y redacción de un segundo artículo que describe efectos que tiene el vehículo de transfección sobre el cambio de actividad de linfocitos, lo cual podría ser un efecto indeseado o uno que potencialmente pueda ser aprovechado como un efecto terapéutico para la transfección.
FPP-FP-005-2023 Evaluación de la eficacia de un tratamiento experimental para la enfermedad de Chagas usando fracciones purificadas a partir de plantas del género Hamelia recolectadas en Sarapiquí y la Península de Osa.
Se dilucidó la estructura de los compuestos activos y se están realizando experimentos de mecanismo de acción para metabolómica. Además, se están realizando análisis estadísticos sofisticados para resultados de actividad contra amastigotos.
1 2 3 5 4 70
Proyecto Fondos Públicos
FPP-FP-006-2023 Huella genética de melina.
FPP-FP-007-2023 Abordaje inicial del bioproceso de obtención de ácido lipoteicoico a partir de Lactobacillus rhamnosus GG para futuras aplicaciones.
FPP-FP-008-2023 Desarrollo de un producto alimenticio a partir de biomasa microalgal de Arthrospira maxima con alto valor alimenticio (FEES).
FPP-FP-009-2023 Estudio de los mecanismos de defensa fisicoquímicos y microbiológicos de los huevos de aves de bosque de Costa Rica.
FPP-FP-010-2023 Caracterizar las comunidades microbianas que habitan la Caverna del Amblipigida y evaluar su potencial para la producción de antibióticos - SIPPRES.
FPP-FP-011-2023 Verificación de balanzas analíticas. FPP-FP-012-2023 Catálogo de servicios Químicos.
FPP-FP-013-2023 Validación de protocolos necesarios para evaluar efecto cardioprotector de productos naturales y medicamentos.
FPP-FP-014-2023 Análisis metabolómicos no dirigidos.

Descripción general
Los datos obtenidos de este proyecto ya fueron generados y procesados con sus resultados listos, el estudiante con el cual se trabajó el proyecto no presentará su tesis debido a su renuncia del programa de posgrados; sin embargo, el proyecto ya finalizo.
Actualmente la última actividad realizada corresponde a la validación del kit ELISA. Las actividades pendientes son: aplicación de química analítica sobre la caracterización de la molécula de interés y escalado del bioproceso.
Ya se encuentra finalizada la etapa experimental. Las actividades pendientes son la interpretación de resultados experimentales.
Fueron recibidas las 31 muestras de comunidades microbianas y se analizaron los datos, además se realizó la identificación molecular de 140 muestras del total, llegando a 200 muestras identificadas al menos a nivel de género. Se realizaron pruebas de actividad antimicrobiana de las muestras restantes para completar el total de muestras.
Se realizaron una serie de revisiones de la colección de aislamientos activos, respecto a las pruebas de actividad antimicrobianas. Ya fue redactado el manuscrito, el cual se va a someter posterior a las últimas correcciones de los demás autores.
Se procedió con la realización del protocolo de uso y verificación de balanzas, las estructuras de cálculos y de reporte de verificación (objetivos 1 y 2). Posterior se hizo una revisión de los documentos generados. El proyecto se encuentra finalizado.

Actualmente se está en proceso de actualización de la página web del CENIBiot (objetivo II).
Se están estableciendo los protocolos de metabolómica en sangre y extracción de ADN de comunidades microbianas para metagenómica.
Se cuenta con los protocolos correspondientes y se está trabajando paralelamente en el procedimiento para el tratamiento, anotación y visualización de los datos (objetivos I y III).



6 7 8 9 10 11 12 13 14 71



Descripción general Proyecto Fondos Públicos

FPP-FP-015-2023 Cuantificación de aminoácidos libres mediante LC-MS/MS.
FPP-FP-016-2023 Análisis del perfil químico de fracciones activas de Witheringia solanacea por espectrometría de masas de alta resolución.
FPP-FP-017-2023 Análisis del perfil químico de fracciones alcaloidales de plantas del género Amaryllidaceae.
FPP-FP-018-2023 Evaluación de potenciales microorganismos degradadores de hidrocarburos aislados de un pozo petrolero abandonado ubicado en el Parque Nacional Cahuita.



FPP-FP-019-2023 Desarrollo de un modelo de síndrome metabólico en ratones.
FPP-FP-020-2023 Optimización de ensayos de biocompatibilidad in vitro para dispositivos biomédicos y biomateriales.
FPP-FP-021-2023 Laboratorio de Bioprocesos en foco: Una documentación visual.

Se cuenta con linealidad, repetibilidad y reproducibilidad validado y se está trabajando en el porcentaje de recuperación para evaluar el tratamiento de muestra.
Los datos obtenidos del proyecto serán utilizados para la redacción de la publicación, el proyecto se encuentra finalizado.
Se estaba a la espera de la recepción de la muestra a analizar enviada desde Chile el 20 de noviembre. Actualmente se encuentra en el proceso de análisis de la muestra.
Actualmente, se continúa trabajando en el análisis gráfico de los genomas ensamblados, para posteriormente aplicar alguna herramienta para detectar los genes asociados con la degradación de hidrocarburos, y comparar a nivel genómico cada microorganismo ensamblado y anotado.


El proyecto se encuentra en etapas iniciales, por lo que se está planificando la reproducción de los ratones C57BL/6Cr.
El proyecto está en fases iniciales, en revisión de literatura y elaboración de protocolos.
El video fue grabado con la colaboración del equipo de Base Camp y las investigadoras de Bioprocesos. En este momento se está editando el material audiovisual para ser publicado en el 2024.

15 17 16 18 19 20 21 72

CNCA




Plan Anual Operativo CNCA (CeNAT-CONARE) 2023 Publicaciones científicasDivulgación Público Privado Total 12 0 12 Actividades de transferencia de conocimiento 50 1 51 Proyectos de investigación 13 2 15 DISTRIBUCIÓN DE LAS METAS ALCANZADAS INDICADORES Atención de estudiantes 14 2 16 Convenios 3 0 3 Funcionamiento del clúster (días) 365 365 Aprovechamiento del clúster (horas) 85.363 85.363 74
INTRODUCCIÓN

El CNCA se presenta como un entorno interdisciplinario y multisectorial que conecta la academia, el gobierno, la industria y la sociedad. Su distinción radica en la calidad sobresaliente de su investigación e innovación. Esta excelencia se refleja tanto en su gestión institucional como en su filosofía en la cual se destaca la transparencia y la rendición de cuentas en todas las facetas de sus labores, desde los proyectos hasta las colaboraciones y transferencias de conocimiento.




Se constituye como un espacio multidisciplinario donde el descubrimiento científico y la innovación tecnológica son acelerados por medio del uso de una infraestructura de computación avanzada. Esta infraestructura incluye no solamente un hardware especializado y actualizado, sino también un conjunto de aplicaciones eficientes y un personal entrenado para aprovechar toda esa tecnología. Esta infraestructura permite al CNCA trabajar en las dimensiones centrales de desarrollo de proyectos de investigación, capacitación y prestación de servicios. sobresaliente de su transparencia y la rendición de El objetivo principal del CNCA es proporcionar dos pilares fundamentales para el avance científico en la comunidad nacional e internacional. Además de la teoría y la experimentación, se reconoce la importancia crucial de la simulación y el análisis de datos en la exploración de nuevas fronteras del conocimiento. Para lograr esta meta, herramientas computacionales, tanto de hardware como de software, son esenciales. Así, los miembros del CNCA se centran en el clúster computacional y las aplicaciones instaladas en él, buscando proporcionar una infraestructura computacional de excelencia que facilite el desarrollo de proyectos y servicios con impacto significativo en la sociedad.









75
Objetivo desarrollode
Fomentar el uso de la computación avanzada en investigaciones con información compleja que aceleren el desarrollo y la innovación de la ciencia-tecnología en Costa Rica.

Misión

Somos un laboratorio que desarrolla investigación interdisciplinaria por medio de computación avanzada para resolver problemas complejos, acelerando la innovación científica y tecnológica.
Visión
Ser un laboratorio de computación avanzada autosostenible con infraestructura tecnológica avanzada, que genere alto impacto en la innovación y el desarrollo de la sociedad y el ambiente, a nivel nacional e internacional.
76
Valores y principios organizacionales
Se presenta a continuación los valores y principios medulares del accionar del CNCA en todas sus actividades:



Valores
Disposición a las buenas relaciones humanas
Disposición al aprendizaje permanente
Innovación colaborativa en el quehacer del laboratorio
Principios
Creatividad en la transferencia de conocimientos
Comunicación permanente del equipo de trabajo
Uso eficiente de los recursos
Gestión colaborativa en los proyectos que se emprenden
Computación Científica
Áreas de Desarrollo
Bioinformática
Acelerar la innovación y el desarrollo Computación de Alto Rendimiento
Ciencia de Datos
Inteligencia Artificial Infraestructura
Redes Avanzadas
Computacional
77
Objetivos estratégicos
Usando como base las áreas críticas se desarrollaron los objetivos estratégicos para proveer mecanismos que permitan alcanzar las metas establecidas:
Desarrollar flujos de trabajo y metodologías que permitan la implementación de agentes informático que simulen habilidades del aprendizaje o la inteligencia humana.
Desarrollar análisis de datos genómicos y metagenómicos
Desarrollar procesos de investigación en la aplicación de técnicas de computación avanzada
Desarrollar flujos de modelado y simulación computacional
Desarrollar procesos de investigación en la aplicación de métodos de manejo y análisis de gran cantidad de datos (Big Data)
Promover el uso de servicios de la red avanzada, fomentando la investigación académica, y la creación de proyectos y comunidades científicas.
Desarrollar y monitorear la infraestructura computacional del supercomputador Kabré, así como dar soporte a sus usuarios
Nodos estratégicos
Mantenimiento del clúster computacional con equipo actualizado.
Desarrollo de la carrera profesional para el recurso humano.
Captación de fondos por medio de venta de servicios y fondos externos de investigación.
Divulgación efectiva de los resultados.
Producción científica sustancial y desarrollo de proyectos de investigación de alto impacto.
Oferta apropiada en capacitaciones para diferentes dominios científicos e ingenieriles


78








Indicadores Impacto 79
CONOCIMIENTO TRANSFERENCIAS DE
TOTAL 51


8 Seminarios de computación avanzada, donde un experto en la aplicación de la computación de alto rendimiento en un dominio científico particular presenta sus resultados.
1 Taller sobre “Paralelismo de Tareas” impartido por el director del laboratorio.
Capacitaciones de programación en introducción a la programación, computación científica y aprendizaje automático con el lenguaje Python para diferentes dominios científicos.
Capacitaciones de programación en introducción a la programación, análisis estadístico y visualización de datos con el lenguaje R para diferentes dominios científicos.
Taller sobre “Adaptive Message Passing Interface” impartido por el director del laboratorio. 6
Taller sobre “Introducción a la programación en C (Preescuela HPC School 2023)”
Talleres sobre el uso de Kabré y Linux.
Capacitaciones de procesamiento Bioinformática de datos genómicos y metagenómicos.


Escuelas de programación en temas de Big Data: Costa Rica Big Data School Limón y Costa Rica Big Data School Puntarenas en modalidad presencial.
Ponencias nacionales en congresos académicos, reuniones, seminarios y foros.
Presentaciones internacionales sobre temas de computación de alto rendimiento en un dominio científico nacional e internacional
Escuela de programación en temas de computación avanzada: Costa Rica High Performance School.


beneficiadas: 663 4 2 1
Personas
1 6 2 7 12 1
80
IMPARTIDAS










TOTAL 16 Atención de estudiantes 14 Fondos Públicos Becas Horas estudiante, asistente y graduados 6 8 2 Fondos Privados Horas estudiante, asistente y graduados 2 81



fondos FEES proyectos internos proyectos fondos
Infraestructura computacional
365
946




cuentas con acceso a los servicios de infraestructura computacional
horas ciencia en simulaciones y procesamiento de datos
100% días al año de funcionamiento de los servicios computacionales que dan como resultado:
85.363 de la disponibilidad del servicio del clúster computacional
15
Proyectos de investigación ciencia computacional y computación paralela y distribuida. 3 8 2
Proyectos de investigación TOTAL
proyectos
CONARE
13 Fondos Públicos 2 Fondos Privados
82
El laboratorio ha logrado articulaciones con las siguientes instituciones y organizaciones Articulaciones

MICITT-CONICIT
MINAE

MAG
Ministerio de Salud
Universidades Públicas (UCR, TEC, UNA, UNED, UTN)
INA
Colegios Profesionales (CPIC)
MOPT
Cámara TIC
Lawrence Livermore National Laboratory
SCALAC
BSC
CSUCA
Asociación de profesionales de la CGR
JUPEMA
INTA
CENIA (CHILE)
ICE
UCIMED
Ministerio de la Presidencia
Aviación Civil M. Seguridad Pública
Banco Popular
INEC
Ministerio Relaciones exteriores
Ministerio de Educación Pública
CONAVI
Cámara Industrias de Costa Rica
LANAMME
Ministerio de Hacienda
Procomer
CINDE
CNFL
COMEX
Ministerio de Vivienda y Asentamientos Humanos
Contraloría General de la República
Inst. Nac. de Innovación y Transferencia en Tecnología Agropecuaria
RECOPE
SENARA
AYA
Cámara de Turismo
Cámara TIC
ICAFE
Sindicatos
Asoc. Prof. CGR
CANAPEP
CANAPALMA
CORFOGA
Coop. Internacional
Armada USA
Lawrence Livermore National Laboratory
SCALAC
BSC
CPIC
83
Convenios
Convenios nacionales para trabajar en el campo de computación avanzada.
RedCONARE
Uno de los servicios de RedCONARE y los departamentos TIC de las universidades es Eduroam, el cual posee los siguientes indicadores: TOTAL



Servicios de la red a disposición de aproximadamente 125000 Estudiantes, funcionarios y profesores
Acceso a Eduroam internacionalmente en 106 países que participan del despliegue de la red de conectividad
Se poseen más de 2 billones de autentificaciones de la Red Eduroam en territorios internacionales
Red Eduroam desplegada en las sedes y recintos de las 5 universidades públicas. Centros de investigación y el edificio CONARE-CeNAT
84
2




Resumen de Proyectos

PROYECTOS FONDOS FEES
Proyecto
Análisis del plasmidoma microbiano en aguas contaminadas y sus posibles efectos en la salud y el ambiente
RedCONARE
Mesa de Ciencia de Datos
Descripción general
Este proyecto busca caracterizar la diversidad y tipología del conjunto de plásmidos (plasmidoma) en la columna de agua, el sedimento, y microplásticos de poliestireno expuestos diferentes puntos de la cuenca del Rio Virilla, por lo que se propone generar información científica novedosa sobre la ecología de plásmidos en ambientes acuáticos, y el efecto de la contaminación sobre la transmisión de estos y sus genes de importancia para la salud pública
El principal objetivo de las redes avanzadas es servir como una herramienta fundamental para fomentar la investigación científica, mejorar la salud a través de la educación médica, la investigación y la telesalud, así como también potenciar la educación mediante el almacenamiento y la distribución eficiente de contenidos educativos, facilitar la colaboración interinstitucional, permitir el acceso a instrumentos y laboratorios remotos, y ofrecer servicios de red que faciliten la conectividad y la transferencia de datos de manera ágil y segura
El objetivo de la mesa de trabajo de Ciencia de Datos y Visualización es promover un amplio proceso de investigación que abarque desde el conocimiento profundo de las materias objeto de estudio hasta la comunicación efectiva de los resultados a través de visualizaciones. Esto implica la recolección de datos de fuentes digitales, el uso de técnicas de programación para organizar la información y análisis estadísticos sofisticados. Al adoptar este enfoque, se busca establecer una nueva forma de recuperar y analizar información de manera expedita y precisa. Esto permitirá un abordaje más completo sobre temas relacionados con el desarrollo humano, utilizando fuentes de información innovadoras para avanzar en la comprensión y la toma de decisiones informadas.
1 2 3
85
PROYECTOS FONDOS CONARE
Descripción general Proyecto
Advancing plasma physics computer simulations with the latest high performance computing techniques
Uncovering novel microbial symbioses occurring in wasps and beetles from Costa Rica.
El objetivo de este proyecto radica en el entendimiento del impacto de las últimas tecnologías en programación paralela para simulaciones de física de plasma, tanto desde el punto de vista de desempeño como de programación
El objetivo principal de este proyecto es explorar y describir detalladamente las relaciones simbióticas entre insectos y microbios. Este enfoque se basa en el interés compartido por los grupos de investigación, quienes han investigado la evolución química, la ecología y las interacciones moleculares en simbiosis insecto-bacteria, así como su potencial aplicativo en la agricultura y la medicina tropical. Este proyecto busca profundizar en la comprensión de estas relaciones simbióticas, identificando nuevas perspectivas y aplicaciones en el campo de la ecología microbiana. Esta investigación contribuirá al avance del conocimiento en este campo y sentará las bases para futuras investigaciones en el área.

PROYECTOS INTERNOS
Descripción general Proyecto
Aprendizaje Automático aplicado al reconocimiento bioacústico de aves tropicales
Se propone aplicar modelos de aprendizaje profundo para detectar y clasificar diversas especies de aves tropicales a partir de archivos de audio disponibles, explorando y preparando los formatos de estos archivos en los repositorios de cantos de aves para su posterior análisis en el reconocimiento de especies en Costa Rica. Se busca identificar y comparar distintos mecanismos de aprendizaje profundo para este fin, con el objetivo de encontrar la técnica más confiable. Se pretende construir un flujo de trabajo para un sistema de reconocimiento y clasificación de cantos de aves, considerando los formatos de archivos disponibles y las técnicas de aprendizaje profundo seleccionadas, así como los procesos necesarios para la clasificación y etiquetado de los cantos. Este flujo de trabajo será evaluado con datos reales de repositorios bioacústicos mediante análisis del rendimiento del sistema en términos de precisión y exactitud, identificando posibles mejoras para futuras implementaciones
1 2
1
86

rendimiento y redes avanzadas.

GPU-accelerated RICH Decoding in Allen


modelado, la simulación, la programación paralela, la computación de alto rendimiento y las redes avanzadas. Se examinará el estado actual de la tecnología de gemelos digitales y su potencial implementación en sectores específicos de interés nacional. Se delimitará el estudio a componentes específicos relacionados con el modelado, la simulación, la computación de alto rendimiento o las redes avanzadas. Posteriormente, se desarrollará un prototipo que integre algunos de los componentes principales de los gemelos digitales. Además, se buscarán alianzas con universidades y organizaciones interesadas en promover la investigación y aplicar esta tecnología en beneficio de los sectores nacionales pertinentes

El objetivo principal de este proyecto es desarrollar un algoritmo de GPU dentro del framework Allen para la decodificación de detecciones en los detectores RICH del LHCb. Esto se logrará mediante la creación de una implementación inicial del código RICH en CPU, que funcionará dentro del framework Allen-GAUDI. Posteriormente, se realizará una implementación del código RICH en GPU para el framework Allen standalone, aprovechando así el potencial de procesamiento masivo que ofrecen las tarjetas gráficas. Finalmente, se trabajará en optimizar y paralelizar el código RICH en Allen para su ejecución en un clúster con GPUs, lo que permitirá una mayor eficiencia y velocidad en el procesamiento de datos de los detectores RICH del LHCb. Este proyecto tiene como objetivo mejorar significativamente el rendimiento y la capacidad de análisis de los datos de los detectores RICH, contribuyendo así al avance de la investigación en física de partículas en el LHCb

5 87
Descripción general Proyecto
Desarrollo de herramientas de inteligencia artificial para el análisis de datos electrocardiográficos
Mejoramiento de la plataforma computacional Kabré
Se propone elaborar e implementar soluciones computacionales avanzadas que faciliten el análisis de datos y la aplicación de inteligencia artificial para la detección de anomalías en registros electrocardiográficos. Esto incluirá un estudio exhaustivo del estado del arte para identificar soluciones basadas en IA. Se establecerá una base de datos de entrenamiento y etiquetada que contendrá registros electrocardiográficos para su análisis posterior. Se desarrollará un modelo de IA capaz de identificar enfermedades cardíacas y otras condiciones relacionadas mediante el análisis automático de datos electrocardiográficos recopilados de centros médicos del país. Este enfoque permitirá mejorar la detección temprana y el diagnóstico preciso de enfermedades cardíacas, lo que podría tener un impacto significativo en la salud cardiovascular de la población
Se plantea el refinamiento y la optimización de los sistemas de administración, seguridad y accesibilidad de los recursos computacionales del clúster Kabré con el objetivo de reducir los tiempos de espera en las colas de trabajos, mejorar la seguridad del sistema y gestionar de manera más eficiente los recursos disponibles. Esto incluirá la optimización del tiempo de respuesta de los sistemas de archivos como NFS y LUSTRE, la implementación de mejores mecanismos de accesibilidad a través de plataformas como Open OnDemand, y la optimización de la herramienta de administración de recursos SLURM. Además, se fortalecerá la seguridad de la plataforma mediante la implementación de sistemas de monitoreo y la introducción de la autenticación de doble factor. Estas medidas trabajarán en conjunto para mejorar la eficiencia, seguridad y accesibilidad del clúster Kabré, beneficiando a los usuarios y maximizando el rendimiento del sistema

Simulación hidrográfica en hidráulica de ríos en GPU´s

Se propone establecer un flujo de simulación completo que incluya la generación y análisis de datos de cuencas hidrográficas para evaluar el riesgo de inundaciones en regiones costarricenses. Este flujo de trabajo implicará el desarrollo de una simulación hidrológica de ríos utilizando el código SERGHEI en GPUs, adaptando el mismo para su ejecución eficiente en este tipo de procesadores. Se llevarán a cabo simulaciones hidrológicas de varios ríos del país para comprender su dinámica bajo diversas condiciones. Posteriormente, se desarrollará un entorno de postprocesamiento y visualización de datos hidrológicos en Python, utilizando herramientas como Xarray, Matplotlib y NumPy para facilitar el análisis de los resultados obtenidos. Además, se añadirá un módulo adicional al código SERGHEI para resolver la ecuación de Exner, considerando el transporte de sedimentos y la erosión, lo que permitirá una evaluación más completa y precisa del comportamiento de los ríos en relación con el riesgo de inundaciones en las regiones costarricenses


6 7 8 PROYECTOS INTERNOS 88
PROYECTOS FONDOS PRIVADOS






Descripción general Proyecto
RISC2: A network for supporting the coordination of Computing research between Europe and Latin America
Red Centroamericana para el Manejo de Datos Epidemiológicos




El proyecto RISC2 tiene como objetivo principal fomentar una cooperación más sólida entre las comunidades industriales y de investigación en aplicaciones de Computación de Alto Rendimiento (HPC) y despliegue de infraestructura, en un contexto donde el uso extendido de la HPC está generando nuevos beneficios en áreas como la industria, la atención sanitaria y la economía. Para lograr este objetivo, el proyecto reunirá a ocho actores europeos clave en HPC, junto con los principales actores de HPC de Brasil, México, Argentina, Colombia, Uruguay, Costa Rica y Chile. Este esfuerzo colaborativo será guiado por un Board externo compuesto por destacados expertos de América Latina y Europa. RISC2 promoverá el intercambio de mejores prácticas a través de reuniones, talleres y capacitaciones, organizados para coincidir con los principales eventos de HPC en Europa (como ISC y EuroHPCSW) y en América Latina (como CARLA e ISUM). Este enfoque busca fortalecer la coordinación y el intercambio de capacidades entre regiones aliadas, reconociendo la importancia estratégica de las intensas inversiones en HPC para mantener la competitividad a nivel mundial
El objetivo del proyecto es realizar una caracterización regional de las olas de casos de infección por Covid-19 en Costa Rica y Guatemala. Este análisis busca comprender la dinámica de la enfermedad en estas regiones mediante el estudio detallado de los datos epidemiológicos disponibles. Se pretende examinar la distribución geográfica de los casos, la evolución temporal de las olas de infección, las tasas de incidencia y la gravedad de los brotes en diferentes áreas. Además, se busca explorar posibles correlaciones con variables demográficas, socioeconómicas y de salud pública para identificar factores que puedan influir en la propagación y el impacto del virus en cada país. Este enfoque integral ayudará a informar la toma de decisiones en materia de salud pública y a orientar la implementación de estrategias de control y prevención de la Covid-19 en Costa Rica y Guatemala
1 2
89

PRIAS









Público Privado Total 1 4 3 16 1 11 0 3 0 14 Plan Anual Operativo PRIAS (CeNAT-CONARE) 2023 DISTRIBUCIÓN DE LAS METAS ALCANZADAS INDICADORES 91
INTRODUCCIÓN
PRIAS es un laboratorio de Geomática con énfasis en la Observación de la Tierra que aporta al país información de alta precisión y disponible a todo usuario a nivel mundial teniendo como fin atender retos y promover estudios sobre el territorio nacional e internacional. Adscrito como Laboratorio al Centro Nacional de Alta Tecnología (CeNAT), el cual es un programa del Consejo Nacional de Rectores (CONARE), se alcanza la promoción y el desarrollo de actividades de investigación científica en diversos campos.
El laboratorio PRIAS es enlace nacional de misiones aerotransportadas de corte científico, el cual mediante técnicas de Observaciones de la Tierra lleva a cabo estudios ambientales y cartográficos que permiten generar información de relevancia para los tomadores de decisiones y creadores de políticas públicas nacionales e internacionales. Su creación permitió a Costa Rica ser uno de los pocos países en el mundo en tener una colección de fotografías aéreas, con diferentes sensores, que registra más del 80% del territorio nacional. Además, la sinergia entre instituciones creada en esos primeros años impulsó el modelo de desarrollo triple hélice que se mantiene hasta la actualidad, y que lleva implícito un impacto y efecto multiplicador de esfuerzos que se realizan en el territorio costarricense.
PRIAS está conformado por un equipo de alto rendimiento multidisciplinario y mantiene una estrecha relación con instituciones del sector académico, público y privado a nivel nacional e internacional, a fin de fomentar la investigación científica, la innovación y la transferencia del conocimiento, a través de la adquisición, tratamiento, almacenamiento, análisis, representación y difusión de la información enfocada desde las Observaciones de la Tierra en las áreas de Sistema de posicionamiento global, Teledetección, Fotogrametría, Sistemas de Información Geográfica, Infraestructura de Datos Espaciales, Geodesia y Ciencias de la Computación que forman parte de la ciencia de la Geomática.

El presente informe concentra las actividades llevadas a cabo durante el año 2023, las cuales muestran logros y avances importantes en las siete áreas de la Geomática mencionadas anteriormente y con aplicaciones hacia las Observaciones de la Tierra, así como la vinculación con el sector académico-público-privado.
92

Objetivo desarrollode


Desarrollar investigaciones en observaciones de la tierra que aporten al conocimiento del territorio costarricense por medio de proyectos de ciencias geo-aeroespaciales aplicadas que propicie la capacidad de toma de decisiones en el ámbito académico, socioeconómico y ambiental.


Misión




Somos un laboratorio de investigación en observaciones de la tierra conformado por un equipo especializado de personas profesionales que trabaja con los más altos estándares científicos, articulado con la educación superior de Costa Rica en el marco de innovación con el sector público, privado, social y la cooperación internacional.
Visión
Ser un laboratorio científico de investigación autosostenible que aporte conocimiento de alto valor en temas de innovación en gestión geoespacial, la catalización aeroespacial y el desarrollo geoinformático, a nivel académico, socioeconómico y ambiental en la región.
93
Valores presentes en el PRIAS
Comunicación efectiva en el trabajo colaborativo
Disposición al aprendizaje multidisciplinario
Creatividad para enfrentar mejoras
Compromiso con las metas que se plantean en cada proyecto
Apertura a la gestión del cambio


Principios presentes en el PRIAS
Uso eficiente de la infraestructura tecnológica
Trabajo colaborativo interdisciplinario
Transferencia de conocimiento adaptada a las poblaciones
Disposición para una mejora constante de los proyectos que se emprenden

Estructura
Operativa:
Innovación en observaciones de la Tierra
Gestión
geoespacial Desarrollo Geo-informático Catalización Aeroespacial
94
Objetivos estratégicos
Fortalecer la administración y rigurosidad científica de los datos geoespaciales para la toma de decisiones basadas en datos
Generar soluciones informáticas para optimizar los sistemas de datos geoespaciales
Integrar el desarrollo de tecnologías y ciencias transformadoras para la rigurosidad del conocimiento y la toma de decisiones prospectivas


Sistemas de información geográfica
Sistema de posicionamiento global
Ciencia computacional
Infraestructura de datos espaciales
95

















TOTAL 4 3 Indexadas
1 Especializadas


Indicadores Impacto PUBLICACIONES
96










TOTAL 16 7 Nacionales CONOCIMIENTO TRANSFERENCIAS DE Personas beneficiadas: 568 Talleres Charlas Simposios 3 3 1 9 Internacionales Talleres Congreso 1 8 Talleres y/o cursos a Universidades Ponencias, simposios, congresos CEC: 230 GLOC: 15 RIAO Optilias: 18 TEC: 20 Experiencias de Educación Ambiental: 50 AMERIGEOS: 135 Evento PRIAS: 43 57 511 97


de investigación TOTAL 11 Internos PRIAS CeNAT-Operativo 9 1 TOTAL 14 Becas Pasante Trabajos Finales de Graduación Estudiantes Asistentes 8 1 1 4 Atención de estudiantes 10 Públicos Otros Fondos 1 1 Privado Propuesta Espectrorradiometría de Salinas Arqueológicas en la Bahía Salinas
Indicadores ODS 11.3.1 y 11.7.1 Propuesta sitios prioritarios Korea-LAC Tech Corps 4 Proyectos en negociación 98
Proyectos
Propuesta



Articulaciones
10
Sector académico nacional
Tecnológico de Costa Rica
Universidad de Costa Rica
Universidad Estatal a Distancia
Universidad Nacional de Costa Rica
Universidad Técnica Nacional
Universidades o institutos internacionales
AMEXCID 22
Agencia de los Estados Unidos para el Desarrollo (USAID)
Asociación
Centroamericana de Aeronáutica y del Espacio (ACAE)
Banco Interamericano de Desarrollo (BID)
Centro Aeroespacial Alemán (DLR)
Centro de Referencia
Copernicus de la Universidad de Chile
Fondo Mundial para el Medio Ambiente (GEF)
Global Fishing Watch
Google Earth Engine
Natural Capital Project
Organización de las Naciones Unidas para la Alimentación y la Agricultura (FAO)
Programa de las Naciones Unidas para el Desarrollo (PNUD)
Secretaría del Grupo de Observaciones de la Tierra (GEO)
Sistema de la Integración
Centroamericana (SICA)
Sistema Regional de Visualización y Monitoreo (SERVIR)
System for Earht observations, data access, Processing & Analysis for Land monitoring (SEPAL)
Unión Internacional para la Conservación de la Naturaleza (UICN)
Escuela de Protección Civil México (ENAPROC)
RSTAG
Universidad Texas Tech
Universidad de Sevilla Universidad Internacional de la Florida
99
TOTAL 72
Universidades o institutos nacionales
Centro Agronómico Tropical de Investigación y Enseñanza (CATIE)
Centro Nacional de Información Geoambiental (CENIGA)
Comisión Nacional de Prevención de Riesgos y Atención de Emergencias (CNE)
Comisión Nacional Para la Gestión de la Biodiversidad (CONAGEBIO)
Dirección de Gestión de Calidad Ambiental (DIGECA)
Dirección General de Aviación
Civil Fondo Nacional de Financiamiento Forestal (FONAFIFO)
Instituto del Café de Costa Rica (ICAFE)
Instituto Interamericano de Cooperación para la Agricultura (IICA)
Instituto Meteorológico
Nacional de Costa Rica (IMN)
Instituto Nacional de Estadística y Censos de Costa Rica (INEC)
Instituto Nacional de Tecnología Agropecuaria (INTA)
Ministerio de Agricultura y Ganadería (MAG)
Ministerio de Ambiente y Energía (MINAE)
Ministerio de Vivienda y Asentamientos Humanos (MIVAH)
Municipalidad de San José.
Programa Estado de la Nación (PEN)
Red SIRGAS (Sistema de Referencia Geocéntrico para América del Sur)
Registro Nacional de Costa Rica
Secretaría de Planificación
Sectorial de Ambiente, Energía, Mares y Ordenamiento Territorial (SEPLASA)
Secretaría REDD (Reducción de Emisiones derivadas de la Deforestación y la Degradación de los bosques)
Sistema Nacional de
Información Territorial (SNIT)
Sistema Nacional de Monitoreo de Cobertura y Uso de la Tierra y Ecosistemas (SIMOCUTE)
Tribunal Ambiental
Administrativo (TAA)
RedClara
Museo Nacional
Grupo de Ingeniería
Aeroespacial
Compañía Nacional de Fuerza y Luz
Centro Científico Tropical
Clodomiro Picado
Red Educadores Ambientales
OET
MICITT
Instituto Nacional de Vivienda y Urbanismo

34 100
EO Data Science
Planet Inc..
Space Generation Advisory Council
UNAQ
Orbital Space Technologies
Astralintu Space Technologies
NASA Space Apps Challenge
International Astronautical Federation





Empresas internacionales 8
101


Convenios
TOTAL 3
Nacionales
Municipalidad de San José. Centro Científico Tropical. Tribunal Ambiental Administrativo.
102




Resumen de Proyectos

FONDOS PÚBLICOS | Proyectos Internos
Descripción general Proyecto
Implementación de almacenamiento distribuido en GeoCenter
Biblioteca de Firmas Espectrales
Implementación de Infraestructura de Datos Espaciales PRIAS
Naves Aéreas No Tripuladas para la Investigación (NANTI)
Aprovechar los recursos del GeoCenter para la implementación de un sistema distribuido de tecnologías de orquestamiento y contenedores dentro del centro de datos del PRIAS, que permita la automatización del despliegue, ajuste de escala y manejo de las aplicaciones en contenedores dentro del centro de datos del PRIAS
Desarrollar una herramienta que permita catalogar, administrar y compartir datos de firmas espectrales colectadas en diferentes proyectos de investigación interna o externa. Así como apoyar el rango de investigaciones en el país por medio del acompañamiento a pasantes, becados CeNAT-PRIAS o practicantes y colaborar en la generación de información de datos hiperespectrales de instituciones dentro de la triple hélice
Desarrollar una implementación web de infraestructura de datos espaciales a partir de la optimización del uso del GeoCenter para ofrecer una variedad de servicios, así como un sistema de inventario de los activos del laboratorio, y alojamiento y monitoreo de los diferentes servicios del GeoCenter
Generar datos para la investigación mediante el uso de UAV’s y fotogrametría. Además, busca apoyar el rango de investigaciones en el país por medio del acompañamiento a estudiantes pasantes, programa de becas CeNAT-CONARE, practicantes y proyectos del laboratorio PRIAS, y colaborar en la generación de información de datos fotogramétricos de instituciones dentro de la triple hélice
1 2 3 4
103
FONDOS PÚBLICOS | Proyectos Internos
Descripción general Proyecto
Reforestación desde el aire
El régimen de incendios forestales en Costa Rica posibles estrategias para la mitigación de su impacto en el bosque seco tropical
Espacialización de la flora arbórea de
Desarrollar herramientas para reforestar desde el aire con cohetería como mecanismo de dispersión y metodología para medir el avance de la reforestación.
Analizar el comportamiento del fuego por medio de variables del régimen de incendios para la generación de modelos predictivos de la distribución espacial de los incendios forestales que brinden información estratégica en la mitigación de daños en el bosque seco tropical.
El mismo se desarrolla en conjunto con la Universidad Estatal a Distancia.
Desarrollar un proyecto piloto para cartografiar la flora arbórea en el Gran Área Metropolitana de Costa Rica, mediante la estandarización de los

Descripción general Proyecto
PRIAS Operativo
El desarrollo de este proyecto está vinculado con el cumplimiento y desarrollo de los indicadores operativos del laboratorio.
5 6 7
104
FONDOS PÚBLICOS | Proyectos en conjunto con el Programa Estado de la Nación (PEN)
Descripción general Proyecto
Estructuras productivas locales: encadenamientos productivos y laborales y cadenas de valor territoriales en Costa Rica.
Representación Geoespacial Histórica Cantonal de Costa Rica período 1905-2014.
Construir la representación espacial en forma de capas de información geográfica que permita reproducir el análisis histórico de las Áreas Silvestres Protegidas para el periodo 1955 hasta la actualidad con el objetivo de encadenarla con otras variables socioambientales
Construir la representación espacial en forma de capas de información geográfica que permita reproducir la división político-territorial hasta un nivel cantonal de Costa Rica para los periodos 1905, 1950, 1963, 1973, 1984, 2014


FONDOS PRIVADOS


Descripción general Proyecto
Proyecto Pilot digital system for monitoring illegal logging in the Golfo Dulce Forestry Reserve and a study area on the pacific side of La Amistad National Park
Desarrollar una metodología que podría implementarse dentro de un Sistema Digital de Monitoreo de Tala Ilegal que permitirá a los gobiernos una mejor gestión de los recursos en el combate de la tala ilegal, corresponde a una investigación conjunta entre el laboratorio PRIAS y la Organización de las Naciones Unidas para la Alimentación y la Agricultura
1 2
1
105
NASA Space

El laboratorio PRIAS tuvo participación en la competencia NASA Space Apps Challenge a través de la analista de infraestructura Stephanie Leitón, el estudiante pasante Andrés Aguilar (Laboratorio PRIAS), la exbecaria Andrea Hidalgo del programa CeNAT-CONARE más la participación de estudiantes del Grupo de Ingeniería Aeroespacial de la UCR y una persona desarrolladora de software.

En esta competencia obtuvieron el primer lugar a nivel local en Costa Rica y fueron nominados para participar por un premio en la competencia a nivel global.
A través de esta participación se logró generar conocimiento que es base para la formación del planteamiento del proyecto del Espacio Creativo del Laboratorio PRIAS.
106
PRIAS 20 años construyendo Investigación Geoespacial

El PRIAS es el primer laboratorio del Centro Nacional de Alta Tecnología en cumplir 20 años dedicado; dentro de la ciencia y tecnología, a transformar conocimiento en desarrollo para el apoyo de la toma de decisiones informadas basadas en datos y colaborando en la democratización de la información.
El 27 de noviembre de 2023, se desarrolló el evento de conmemoración con el propósito de celebrar los 20 años de dedicación y logros, así como reflexionar sobre los hitos alcanzados y el futuro de la investigación geoespacial, se contó con la presencia de embajadores (as), directores (as) de organizaciones públicas, privadas e internacionales, autoridades universitarias y personas investigadoras de gran trayectoria.
107

Ambiental
Gestión







Publicaciones científicasPúblico Privado Total 2 0 2 Actividades de transferencia 15 5 20 2 5 7 2 0 2 8 3 11 Plan Anual Operativo GESTIÓN AMBIENTAL (CeNAT-CONARE) 2023 DISTRIBUCIÓN DE LAS METAS ALCANZADAS INDICADORES 109
INTRODUCCIÓN



El Área de Gestión Ambiental vincula y articula acciones de corte ambiental, climático y agromático, con las universidades de CONARE, instituciones estatales y el sector empresarial, en temas como asesoramiento y búsqueda de alternativas sostenibles en procesos productivos, recursos naturales, buenas prácticas, actividades académicas y capacitaciones especializadas, investigación y aplicaciones en nueva tecnología amigables con el ambiente. El Área es apoyada por representantes de “Gestión Ambiental” de la UNED, UNA, ITCR, UTN y UCR, que conforman el Comité Asesor Académico.


Entre sus objetivos principales está el apoyo, coordinación y proyección en las áreas de Gestión Ambiental de las universidades, el desarrollo de proyectos ambientales y actividades interdisciplinarias con las demás áreas del CeNAT, el manejo y la conservación de los recursos naturales, clima y seguridad alimentaria y apoyo en el mejoramiento de políticas ambientales del país.
110
Objetivo de Desarrollo de Gestión
Ambiental
Difundir y empoderar a la sociedad en los ámbitos económico, social y ambiental en cambio climático, energías limpias, encadenamiento productivo y valor agregado de productos, mediante el desarrollo de procesos de asistencia técnica que impactan territorialmente proyectos de innovación, tecnología y emprendimiento para el desarrollo productivo de Costa Rica.
Misión

Somos un área de investigación con vínculo nacional e internacional, que apoya al sector público, privado y sociedad civil en asistencia técnica para la toma de decisiones ante los riesgos de eventos climatológicos y en el desarrollo productivo, a través de un equipo de profesionales especializado que realiza estudios con los más altos estándares científicos en el marco de innovación y el desarrollo de la educación superior en Costa Rica.
Visión
Ser un área de investigación autosostenible de alto impacto económico y social a nivel nacional e internacional, que aporta en la generación del conocimiento en materia de cambio climático, energías limpias, encadenamiento productivo y valor agregado de productos, siendo líder en el fortalecimiento del desarrollo competitivo y la asistencia técnica desde la articulación intersectorial.
111

Valores presentes en Gestión Ambiental
Cuidado de equipo humano
Apoyo gastronómico y productivo en mejoras contrastantes
Gestión colaborativa en los proyectos que se emprenden
Socialización de la información científica a la sociedad



Principios presentes en Gestión Ambiental
Uso eficiente de los tiempos
Sana gestión administrativa de los proyectos de investigación
Disposición para una mejora constante de los proyectos que se emprenden
Empoderamiento de conocimiento y habilidades


112
Estructura
Operativa:
Áreas de desarrollo estratégico de Gestión Ambiental
Innovación y desarrollo
Asistencia técnica

Cambio climático
Agromática
Energías limpias
Objetivos Estratégicos del área de Gestión Ambiental


Brindar información técnica de variabilidad atmosférica y cambio climático a los sectores productivos de toma de decisiones de Costa Rica y Centro América
Generar acciones colaborativas con comunidades de productores agropecuarios en procesos de mejora y valor agregados de productos
Impulsar el desarrollo de tecnologías y soluciones de transformación energética sostenibles en articulación con actores nacionales e internacionales
Incrementar el conocimiento de las comunidades en temas de gestión ambiental
Procurar la sostenibilidad financiera de Gestión Ambiental
113
Nodos
Estratégicos del área de Gestión
Ambiental

Desarrollo de plataformas informáticas e instrumentos de acceso a la información para tomadores de decisiones, productores y comunidades en temas poblacionales, espaciales, ambientales, climáticos y agroalimentarios
Desarrollo de proyectos conjuntos de apoyo a comunidades y estudios de impacto ambiental con organismos nacionales e internacionales
Impulso de conocimiento y valor agregado de productos mediante estrategias de agromática apegadas a iniciativas nacionales, regionales y mundiales, tales como los planes de SAN-CRLAC, Slow Food, denominaciones de origen, ferias de la madre tierra y otros
114
Programas del Área de Gestión Ambiental
Dirección del Área
La dirección del Área apoya y alinea las acciones estratégicas de los diferentes programas que componen el área. Además, colabora con la gestión de los proyectos desarrollados por el Laboratorio PRIAS.
Por otro lado, impulsa acciones y proyectos de innovación empresarial con proyectos de vinculación europea y de América, enfocados en PYMEs y emprendimientos en alta tecnología. Esto en asocio con el Ministerio de Ciencia, Innovación, Tecnología y Telecomunicaciones (MICITT) y el Ministerio de Economía, Industria y Comercio (MEIC).
Además, y con base en instrucciones de la Dirección General del CeNAT, el Director de Gestión Ambiental coordina el Programa de Becas anuales CeNAT – CONARE, enfocado a estudiantes de grado y posgrado de las universidades públicas, para que desarrollen sus trabajos de graduación o investigación en los laboratorios y/o programas del CeNAT.
Finalmente, y siguiendo las instrucciones de la Dirección General del CeNAT, se apoya el desarrollo logístico de proyectos interlaboratoriales y actividades (congresos, seminarios, otros) de otras unidades del CeNAT.

115
Observatorio Climático
El Programa Observatorio Climático del Área de Gestión Ambiental, responde a la necesidad de fortalecer la capacidad de adaptación ante la variabilidad y el cambio climático que generan variaciones extremas del tiempo y el clima en la productividad del sector Agropecuario.

El Observatorio Climático se dedica a investigar las situaciones pasadas, actuales y las perspectivas del clima con el propósito del beneficio social ante de las adversidades climáticas.
El Observatorio en forma continua y novedosa brinda servicios al sector agropecuario en investigación y capacitaciones, con asistencia personalizada de una plataforma tecnológica en temas de adaptación y resiliencia a la variabilidad y el cambio climático a las comunidades agrícolas, con fin de sostener la productividad y aumentar el rendimiento de los cultivos y ganado; de esta forma ayuda en la toma de decisiones y la planificación de las actividades.
116
El programa de Agromática se dedica a trabajar con apoyo de alianzas y altas tecnologías (con universidades, instituciones, ministerios, empresas, órganos regulatorios y los laboratorios propios del CeNAT),

Se tipifican los productos, su expresión génica, para detectar genes de adaptación al medio, de resistencia a enfermedades y plagas, ligados con la calidad, dureza de acuerdo con la variabilidad de la especie existente. La tipificación es mediante el conocimiento de la calidad organoléptica y culinaria de productos locales, muchos de ellos poco conocidos.
Además, se realizan caracterizaciones morfo agronómicas, fisicoquímicas, organolépticas, y bioquímicas que permitan conocer y valorar los contenidos nutritivos y antinutritivos de los productos y, a través de altas tecnologías, se avalan los pliegos de condiciones técnicas que puedan indicar que el producto es merecedor de un signo distintivo de calidad. Se busca determinar los orígenes y usos de los diferentes productos y el buen aprovechamiento de los subproductos agroindustriales. Estos estudios integrales permiten hacer frente a los desastres naturales, a la variabilidad y cambio climático, a la deforestación y a la pérdida de cosecha que causan el encarecimiento del producto y la inseguridad alimentaria.
Mediante la alianza con Slow Food se desarrollan actividades para promover los productos de calidad, limpios (inocuos y con tecnologías limpias que minimicen el daño a la salud humana, animal y ambiental) y que tengan un precio justo, reduciendo las cadenas de intermediación de forma que ganen tanto el productor y su familia, como el coproductor que es un consumidor consciente que conoce la problemática de los productores y sus familias y los valora por el gran esfuerzo que realizan para brindarle un producto más sostenible y saludable.
117
Indicadores Impacto












TOTAL 2 2 Especializadas




PUBLICACIONES
118













TOTAL 20 15 Público Nacionales (Impartidas) CONOCIMIENTO TRANSFERENCIAS DE Personas beneficiadas: Más de 9000 Charlas Impartidas Talleres, Conversatorios, Cursos impartidos 6 8 5 Privado Nacionales (Impartidas/Recibidas) Charlas Impartidas Talleres, Conversatorios, Cursos impartidos 2 3 Internacionales (Impartidas) Cursos, simposios impartidos 1 Atención a 23 grupos de WhatsApp, 13 grupos de Telegram, plataforma del PIACT, y por medio de la página de facebook. 119
Proyectos de investigación
TOTAL 7
Proyectos en negociación/propuestas
BID: Realización de los talleres de formación para el fortalecimiento del Mecanismo General de Consulta de los pueblos indígenas de Costa Rica
Fondos Erasmus + de fortalecimiento de capacidades centroamericanas


2 Públicos 5
Becas CeNAT-CONARE Estudiantes de becas CeNAT-CONARE 13 3 Horas Asistente Estudiantes en horas asistentes 13 3 Privadas 3 Horas Estudiante Estudiantes en horas estudiantes 12 2 120
TOTAL 11 Atención de estudiantes
Privados
Articulaciones

9

Sector académico nacional
Instituto Nacional de Aprendizaje (INA)
Universidad de Costa Rica (UCR)
Instituto Tecnológico de Costa Rica (TEC)
Universidad Técnica Nacional (UTN)
CTP de San Sebastián
ULACIT
Liceo Santo Domingo
Planta tratamiento de aguas residuales Los Tajos Red Costarricense de Instituciones Educativas Sostenibles (REDIES)
5
3
Universidades o institutos internacionales
Universidad de Mondragón
España
OEI
EU-SOLARES ERIC
LifeWatch ERIC
OBREAL
7
Empresas internacionales
Rawsuns Technologies – China
Embajada de Canadá
El Congreso de las Américas sobre Educación International (CAEI)
Empresas nacionales
MICITT
Promotora Costarricense de Innovación e Investigación
Banco Nacional de Costa Rica (BNCR)
MEIC
Instituto Nacional de Aprendizaje (INA)
Banco Nacional de Costa Rica (BN)
Cámara de Industria de Costa Rica
Banco Popular y de Desarrollo Comunal
121


TOTAL 2
Convenios
122
Banco Nacional de Costa Rica Convenio de la sede del Atlántico de la UCR Nacionales 2




Resumen de Proyectos

Descripción general Proyecto
Proyecto Gestión Ambiental
Proyecto Costa Rica Antártida
Proyecto “Generación de capacidades agroindustriales y creación de una unidad de calidad integral (caracterización fisicoquímica, organoléptica y microbiológica) para el mejoramiento del proceso de producción del queso Turrialba con Denominación de Origen (PINN-ASOPROA)”.
El Área de Gestión Ambiental da apoyo tecnológico e información veraz, pertinente y oportuna a más de 7,500 productores de Costa Rica y toda Centroamérica para la adecuada toma de decisiones
Asimismo, se desarrollan unidades de calidad integral y apoyo productivo a asociaciones de productores.
El proyecto Gestión Ambiental, cuenta con estudiantes que brindan un aporte muy importante en el quehacer del día a día de distintas actividades, proyectos que se desarrollan en el área y sus programas
En este proyecto se continuó y concluyó el diseño del laboratorio móvil alimentado con energías limpias. También se cotizaron y construyeron los diferentes componentes y sistemas tanto de conversión a eléctrico como de la alimentación complementaria fotovoltaica.
Finalmente se coordinó el embarque de los componentes desarrollados en China y se está coordinando con los proveedores locales la compra de repuestos y otros equipos
Después de un año de gestiones, se logró el 20 de diciembre, 2023, la reanudación y extensión del proyecto hasta el 31 de diciembre de 2024.
Se iniciaron coordinaciones con la Presidencia de ASOPROA para continuar con la compra de equipos, implementación de la Unidad de Calidad Integral (UCI) y protección intelectual de los subproductos obtenidos.
1 2 3 123
Descripción general Proyecto
Proyecto Mercado de la Tierra

Proyecto Gestión Ambiental UPS
Proyecto CSUCA: “Fortalecimiento de las competencias ambientales en las comunidades a través de la innovación tecnológica y metodológica para impulsar la resiliencia en la gestión del riesgo a desastres y el cambio climático en el cantón de Heredia, Costa Rica, del distrito De Almirante, De Bocas del Toro, Panamá y de la comunidad indígena Achí, de Rabinal del Departamento de Baja Verapaz, Guatemala.”
Proyecto OEI de "ENERGYTRAN: EULAC FOR ENERGY TRANSITION: RESEARCH INFRAESTRUCTRES COOPERATION FOR ENERGY TRANSITION BETWEEN EUROPE AND LATINAMERICAN AND THE CARIBBEAN COUNTRIES".
Se han desarrollado reuniones con productores y campesinos, en Tucurrique, Turrialba, zona del caribe, entre otros lugares del país. Se está coordinando el mercado de la Tierra 2024 y se ha incrementado el trabajo del apoyo en el PIAM. Para este proyecto se tiene programado la feria del mercado de la tierra para diciembre, por lo que después de tantos años sin poder realizarla, es una actividad muy importante para así poder contar con la participación de chefs, artesanos, estudiantes, entre otras personas que participan muy de lleno con el valor agregado de alimentos locales y seguridad alimentaria.
Se logró la continuidad de la contratación por servicios profesionales, de las personas que dan soporte a la página del PIACT y además al WhatsApp, para las perspectivas climáticas, además. Se ha logrado la ejecución de actividades, giras y de más, de otros proyectos sobre todo el cobro de horas de trabajo que realiza el área en el proyecto PINN.
Para este trimestre se ha continuado con las contrataciones de las personas que están realizando el soporte a la página del PIACT y grupos de chat.
Se logró la aprobación del proyecto, así como la gestión del primer desembolso. Se desarrollaron los planes de trabajo, los primeros materiales de los talleres y se generaron los primeros perfiles para las contrataciones del proyecto
Se presentó la propuesta, misma que fue aprobada por la Unión Europea. Se iniciaron las gestiones administrativas y los planeamientos con el LifeWatch ERIC como líder de los paquetes de trabajo donde se encuentra participando el CeNAT. Se trabajó en el esquema metodológico del proyecto
4 5 6 7 124


APOYO EN TRANSFERENCIAS DEL CONOCIMIENTO


El LANOTEC además de su enfoque al desarrollo de investigación también es primordial la maximización de la labor en el área de extensión y docencia, ya que nos preocupamos por desarrollar y potenciar el fomento de vocaciones científicas desde edades tempranas, procurando un acercamiento con centros educativos para involucrar en el proceso a niños desde el primer ciclo escolar.


Parte del compromiso en esta área se evidencia en la participación de delegaciones estudiantiles en las diversas Olimpiadas de Ciencias y Química, iniciando el proceso a nivel nacional para seleccionar los representantes para la participación en los eventos a nivel internacional.
A nivel nacional se participó en la organización de estos eventos:
XXIII Olimpiada Costarricensede Química



V Olimpiada Costarricense de Ciencias
VII Campamento de Fomento de Vocaciones Científicas Especialmente de la Química
Para el 2023 se realizaron los siguientes eventos a nivel internacional:
XVI Olimpiada Centroamericana y XIV del Caribe de Química
XXVII Olimpiada Iberoamericana de Química
55° Olimpiada Internacional de Química ICHO 2023
20°Olimpiada Juvenil Internacional de Ciencias


Este año se ha dado un paso para volver a la presencialidad realizándose 3 olimpiadas de forma presencial: Olimpiada Centroamericana y del Caribe de Química, la Olimpiada internacional De Química y la Olimpiada Juvenil internacional de Ciencias; y de forma virtual la Olimpiada Iberoamericana de Química.



126
XXIII Olimpiada Costarricense de Química
La olimpiada se realizó de forma presencial, además. Se realizó un examen de laboratorio a los 28 mejores estudiantes de la categoría A que obtuvieron mejor notas en el examen final.

Durante este proceso, se deben preparar y revisar exámenes; participar en los eventos y aportar en la logística de las actividades.
Por otro lado, se realizó una capacitación a estudiantes preseleccionados para que se preparen para las competencias internacionales. Durante este proceso se hacen varias “súper finales” para seleccionar quien participará en las olimpiadas internacionales.
En este año 2023, la Olimpiada Costarricense de Química la siguiente distribución de participantes.
Estudiantes Total de Instituciones 80 Categoría A Alajuela Categoría B 151 165 316 302 233 535 Total de Estudiantes 851 18 Heredia 15 Limón 8 Cartago 7 San José 20 Puntarenas 6 Guanacaste 6 Cantidad de instituciones por provincia 127
V Olimpiada Costarricense de Ciencias

La olimpiada se realizó de forma mixta, el primer examen se hizo en forma virtual y el final se hizo en forma presencial. Además, se realizó una pasantía de laboratorio con los estudiantes que obtuvieron mejor notas en el examen final. En esta pasantía los estudiantes realizaron una práctica de laboratorio y posterior a esto, visitaron a algunos laboratorios donde se les habló de que hace el laboratorio y cuáles son sus alcances.
Durante este proceso, se prepararon y revisaron los exámenes que tienen contenidos de las tres áreas biología, física y química, además de participar en las actividades y llevar la logística de todo el evento.
Por otro lado, se realizó una capacitación anual a estudiantes preseleccionados que se prepararon para la competencia internacional. Durante este proceso se hace una “súper final” para seleccionar quien participaría en la olimpiada internacional.


En este año 2023, la Olimpiada Costarricense de Ciencias tuvo la siguiente distribución de participantes:
Estudiantes Categoría A Categoría B 178 132 310 46 32 78
128











Total Noveno Octavo Séptimo Sexto Quinto Cuarto 105 106 99 42 23 13 388 Nivel Estudiantes Total de Instituciones Cantidad de instituciones por provincia 39 Alajuela 7 Heredia 9 Limón 3 Cartago 5 San José 12 Puntarenas 2 Guanacaste 1 Total de Estudiantes 388 129
VIII Campamento de Fomento de Vocaciones Científicas
Este campamento se realiza con las y los estudiantes finalistas de las olimpiadas costarricenses de ciencias y química. A partir de un análisis de los candidatos se selecciona un grupo de estudiantes de todo el país.
Durante tres días se realizaron charlas, laboratorios, experimentos y actividades lúdicas enfocadas en la química, física y biología, además de trabajar pensamiento crítico y resolución de problemas.
En el 2023 las y los participantes en el campamento se distribuyeron de la siguiente forma




Hombres 23 Mujeres 16 Total 39 Olimpiada Estudiantes Ciencias Química Total 17 22 39 130
Logros:
XVI Olimpiada Centroamericana y XIV del Caribe de Química
La olimpiada se realizó en El Salvador en los días del 2 al 7 de setiembre y los integrantes la delegación de Costa Rica fueron:
Andrea Rivera Álvarez, Jefe de Delegación
Mario Villalobos Forbes, Mentor
Fabian Andrés Flores Alvarado, Estudiante
Isaac Herrera Chaves, Estudiante
Gloriana Carrillo Cabezas, Estudiante
Jorjan Alejandro Madrigal Ugalde, Estudiante

Gloriana Carrillo Cabezas Medalla Bronce
Isaac Herrera Chaves Medalla Bronce
Fabián Andrés Flores Alvarado Medalla Bronce
Jorjan Alejandro Madrigal Ugalde Medalla Plata
131
XXVII Olimpiada Iberoamericana de Química

El examen de teoría se trabajó igual por la plataforma de OlyExam y los estudiantes tuvieron 5 horas en una de las salas de reuniones del CeNAT. La discusión traducción y posterior revisión de pruebas transcurrió sin ningún inconveniente.
El evento fue organizado por Ecuador y se realizó del 02 al 19 de octubre de 2023, la delegación costarricense la integraron:
Wendy Villalobos González, Jefe de delegación
Eduard Ríos Badilla, Mentor(a)
Fabián Flores Alvarado, Estudiante
Jorjan Madrigal Ugalde, Estudiante
Henry Mora Ureña, Estudiante
José Daniel Muñoz Solís, Estudiante
Andrea Rivera Álvarez, Supervisor
Logros:


La olimpiada se realizó de forma virtual, se utilizaron las plataformas de Zoom, Google Drive y de OlyExam; además, las actividades protocolarias se transmitieron por YouTube.

Las reuniones para discusión de pruebas, traducción y juzgamiento se realizaron en la plataforma de Streaming. La prueba de laboratorio se hizo a través de video explicativos subidos a Google Drive y el documento del examen se descargó e imprimió por medio de la plataforma de OlyExam. Esta prueba se realizó en el laboratorio de cómputo del CeNAT.
Jorjan Alejandro Madrigal
Ugalde
Medalla Plata
Fabián Andrés Flores Alvarado
Medalla Bronce
José Daniel Muñoz Solís
Medalla Bronce
Henry Mora Ureña
Medalla Mención de honor
132
55° Olimpiada Internacional de Química
El evento se realizó en Zúrich, Suiza; del 16 al 25 de julio del 2023, la delegación costarricense la integraron:


José Roberto Vega Baudrit, Jefe de Delegación
Manuel Sandoval, Mentor
Randall Syeed, Acompañante, con fondos propios
Juan Pablo Hernández Abarca, Estudiante
Henry Mora Ureña, Estudiante
José Daniel Muñoz Solís, Estudiante
Alexander Sancho Dive, Estudiante

Logros:
No se obtuvieron medallas ni premios, sin embargo, se destaca el compromiso, participación y crecimiento de los estudiantes a nivel académico durante el desarrollo del evento.
133
20° Olimpiada
Juvenil
Internacional de Ciencias


Esta olimpiada fue organizada de forma presencial. Las discusiones, traducciones y juzgamientos se realizaron por los profesores tutores de la delegación. Durante estos periodos se aprueban las preguntas de cada una de las pruebas entre todos los países participantes, se traducen y posteriormente se discuten las notas obtenidas por los estudiantes.
El estudiante tiene tres exámenes que resolver: un examen de selección única, un examen de desarrollo y un examen de laboratorio, cada examen tiene una duración de 4 horas. Durante estas pruebas los estudiantes tienen preguntas de las 3 áreas, química, física y biología. El evento se organizó en Tailandia, del 01 al 10 de diciembre del 2023, la delegación costarricense la integraron:
Andrea Rivera Álvarez, Jefe de Delegación. Mentor Física
Ricardo Ulate Molina, Mentor
Kenneth Castillo Rodríguez, Mentor
Mateo Sancho Dive, Estudiante
Sol Moya Peñaranda, Estudiante
Gabriel Ampie Rojas, Estudiante
Ariana Espinosa Clavera, Estudiante
Sofía Argüello Herrera, Estudiante Logro: Sol Moya Peñaranda Medalla Bronce
134

Emprendimientos:
Apoyo a empresas de investigación científica aplicada


LABORATORIO
LANOTEC
Office of Naval Research Global
ASOPROA Santa Cruz
Boston Scientific de Costa Rica S.R.L.
Calox de Costa Rica S.A.
Phillips Morris
Coopervision Manufacturing
Costa Rica
Alternatives for interface-modified and 2D/3D perovskite absorbers for perovskite solar cell application
PINN: Generación de capacidades agroindustriales y creación de una unidad integral (caracterización fisicoquímico, organoléptico y microbiológico) para el mejoramiento del proceso de producción del queso Turrialba con Denominación de Origen
Análisis de caracterización de materiales
Análisis de caracterización de materiales
Diseño y desarrollo de un modelo de concepto para establecer un estudio bioinformático de cáncer de pulmón por medio de visión artificial de las imágenes 3D de escala nanomolecular y biomarcadores moleculares circulantes de genes asociados
Evaluación del impacto del humo de un cigarrillo vs THS en la calidad del aire interno
Análisis de caracterización de materiales
EMPRESA
136
INVESTIGACIÓN
FIFCO
H2020 - UE - Universidad de Belgardo, Serbia
Hologic Surginal Products
Costa Rica SRL
Proquinal

FIFCO - ISEF BAC Credomatic
Confluent Medical Costa Rica
Abbot Medical
Nextern
UPL Costa Rica
BIO365
Gutis SRL
Nevro Medical SRL
Mejía Azacarate SRL
Smiths Interconnect S.A.
AbbVie
Análisis de caracterización de botellas plásticas
Automated functional screening of IgGs for diagnostics of neurodegenerative diseases (AUTOIgG)
Análisis de caracterización de materiales
Evaluación de la actividad antimicrobiana de cuatro telas vinílicas producidas por la empresa
Eureka – Taller ISEF Fomento de vocaciones científicas y participación en ferias a nivel de secundaria
Tarjetas de crédito BAC
Análisis de caracterización de materiales
Análisis de caracterización de materiales
Análisis de caracterización de materiales
Análisis de caracterización de materiales
Análisis de caracterización de materiales
Análisis de caracterización de materiales
Análisis de caracterización de materiales
Análisis de caracterización de materiales
Análisis de caracterización de materiales
Análisis de caracterización de materiales



EMPRESA INVESTIGACIÓN 137

EMPRESA
Orgánicos Ecogreen
Laboratorio SAVAL
Fertinyc
Universidad Privada del Norte, Perú
INVESTIGACIÓN
Talleres y capacitaciones
Análisis de caracterización de materiales
Prototipo de Biopolímeros, obtenidos a partir de residuos biomásicos piñeros (BIO TAG)
Nanopartículas de metales biosíntetizadas a partir de residuos agroindustriales aplicadas en la funcionalización de bioplásticos para uso en la cadena industrial de berries




LABORATORIO
CENIBiot





EMPRESA
Thrive Natural Care
Nippon Paper Papylia Co., Ltd
Coopetarrazú
Biotech CR. S.A.
Bio CR
INVESTIGACIÓN
Preparación, cuantificación, caracterización y desarrollo de método de extractos estandarizados de material de origen vegetal
Establecimiento in vitro de plantas y protocolos de huella genética
Preparación, cuantificación, caracterización y desarrollo de método de extractos de material de origen vegetal
Identificación molecular (barcoding de ADN) de organismos vivos y desarrollo de protocolos de optimización y escalamiento de bioprocesos
Análisis de control de calidad fisicoquímico para cerveza
138

EMPRESA INVESTIGACIÓN

Corbana S.A.
Corporación de Desarrollo
Agrícola del Monte S.A.
CoopeAgri R.L
Speratum
Laboratorios Stein
CoopeCUNA
Mammoth Biosciences
Granja Avícola Santa Marta
BaseCamp Research
Identificación molecular (barcoding de ADN) de organismos vivos y desarrollo de protocolos de optimización y escalamiento de bioprocesos
Identificación molecular (barcoding de ADN) de organismos vivos
Cuantificación de Polifenoles
Unidad de implementación
Desarrollo y validación de métodos de cuantificación e identificación por técnicas de HPLC y espectrometría de masas

Compund-Foods

Desarrollo, control de calidad y transferencia de conocimiento para procesos de producción de aceites en escala industrial
Descripción de metagenomas microbianos en ambientes extremos
Optimización de protocolos de producción de enmienda biológica orgánica para uso agrícola
Estudio de Diversidad Microbiana a Gran Escala en Costa Rica, además se cuenta con un convenio con la empresa en son de concretar futuros proyectos de investigación
Producción de metabolitos de interés comercial en suspensiones celulares de café y mejoramiento de procesos y protocolos analíticos

Treinta y cinco Fábrica de Cervezas
Establishment Labs
Fruitpoint Costa Rica
Osa Conservation


Almacenamiento y criopreservación de microorganismos
Determinación de la presenciade plastificantes
Liofilización de muestras (Stock de microorganismos mediante liofilización)
Extracción de ácidos nucleicos




Fuente: Información proporcionada por los laboratorios del CeNAT para el 2023.
139




Apoyo a organismos o instituciones de investigación científica aplicada



INSTITUCIÓN APOYO
Ministerio de Ciencias, Innovación, Tecnología y Telecomunicaciones (MICITT)
Ministerio de Agricultura y Ganadería (MAG)
Universidades Públicas (UCR, TEC, UNA, UNED, UTN)
Cámara de Tecnologías de Información (CAMTIC)



CNCA



Advanced Computing System for Latin-American and Caribbean (SCALAC)
Consejo Superior Universitario Centroamericano (CSUCA)


Colaboración para el desarrollo de inteligencia artificial en el país
Apoyo a institutos de investigación en el desarrollo de actividades
Plataforma de computación avanzada para el desarrollo de proyectos de investigación y capacitación
Colaboración en el capítulo de inteligencia artificial
Apoyo en la organización de la estructura de la sociedad

Plataforma de computación avanzada para el desarrollo de proyectos de investigación y capacitación


140
LABORATORIO



Promotora Costarricense, MICITT, DLR, SINAC, MINAE
FAO, SINAC, MINAE y demás usuarios de la información disponible
TEC, Museo Nacional y UTN
SIMOCUTE
CONARE-PEN
Proyecto MONEO-WET: Applicability of Sentinel-2, DESIS and Landsat 8 satellite imagery data for water quality studies, on water bodies, related to crop coverage surroundings of National Wetland Térraba- Sierpe (MONEO-WET). Además, se participó en una pasantía en la Agencia Espacial Alemana
Proyecto FAO-SEPAL: Pilot digital system for monitoring illegal logging in the Golfo Dulce Forestry Reserve and a study area on the pacific side of La Amistad National Park
Proyecto: Espacialización de la flora arbórea de Costa Rica estudio piloto para el Gran Área Metropolitana
Participación en talleres para la actualización del sistema de clasificación del SIMOCUTE
Proyecto Representación Geoespacial Histórica Cantonal de Costa Rica período 1905-2014: Construir la representación espacial en forma de capas de información geográfica que permita la reproducción de la División Territorial Administrativa de Costa Rica para los periodos 1905, 1950, 1963, 1973, 1984 y 2014.
Proyecto Estructuras productivas locales: encadenamientos productivos y laborales y cadenas de valor territoriales en Costa Rica.
PRIAS LABORATORIO
141
EMPRESA
INVESTIGACIÓN
EMPRESA INVESTIGACIÓN

Grupo Asesor Regional sobre Ciencia y Tecnología (RSTAG)
Municipalidad de San José, INEC RedClara

Grupo de Ingeniería Aeroespacial
UNED-LIIT MTF Teca
Participación en las sesiones de trabajo y talleres llevados a cabo por diferentes representantes en el tema de desastres y reducción del riesgo
Oportunidad de colaboración para el cálculo de índices ODS
A través de RedCLARA se invita al laboratorio PRIAS a participar de un webinario sobre la iniciativa del programa Copernicus en latinoamerica, se realiza el Ideaton BELLA para potenciar proyectos de innovación relacionados con Observaciones de la Tierra

ENAPROC, México
Universidad de Sevilla
Proyecto: Reforestación desde el aire: Metodología para evaluar la efectividad de la reforestación con cohetería como mecanismo de dispersión
Proyecto el régimen de incendios forestales en Costa Rica posibles estrategias para la mitigación de su impacto en el bosque seco tropical
Proyecto Biblioteca de Firmas
Espectrales: Estudio Integración del uso de sensores remotos e in situ para la detección de plagas y enfermedades en plantaciones de Tectona grandis L.f. en Nandayure, Guanacaste Costa Rica
Iniciativa Capacidades Comunitarias Bothrops asper


Oportunidades de colaboración entre las cuales se ha valorado un convenio marco, para el apoyo en el levantamiento de firmas espectrales de Salinas
142
GESTIÓN
ÁREA DE AMBIENTAL
EMPRESA

INVESTIGACIÓN
MICITT
FUNDECOOPERACIÓN
OEI
OEI – OCDE
CONARE – GlobalEdu –Procomer
FunCeNAT – CINDE IMN
BID
Asociación de Desarrollo de Desamparados – UNED –UCR
Apoyo a realización de talleres de formación en propuestas de la Unión Europea
Participación en actividad de cierre del mes de la Ciencia, con Stand
Participación en actividad de presentación de proyectos ADAPTA2 en la Antigua Aduana
Noche Iberoamericana
Desarrollo taller paralelo a Reunión Ministerial Latinoamericana de Ministros de Ambiente de la OCDE
Desarrollo Stand Costa Rica CAEI-2023 en Las Vegas
Proyecto BID – Biomateriales
Proyecto BID – Biodesarrollos
Búsqueda de fondos para lanzamiento de sondas meteorológicas, en el marco del PIACT
Presentación de propuestas de investigación en temas de variabilidad y cambio climático
Observatorio de Salud Ambiental de Desamparados
Fuente: Información proporcionada por los laboratorios y Área del CeNAT para el 2023.
143

Para el Centro Nacional de Alta Tecnología es importante la socialización de conocimiento científico que se realiza a través de subsistemas: la educación científica, la comunicación y la divulgación del quehacer institucional del CeNAT.


El CeNAT trabaja para la sociedad, ante esto la comunicación es un puente con la población para difundir el conocimiento científico y los hallazgos que realizan los laboratorios y el área.
El trabajo de comunicación que se desarrolla conlleva la atención de la prensa y solventar consultas de la población en las redes sociales del Centro.
145

En la actualidad la presencia en las redes sociales es fundamental dentro de la estrategia de divulgación, es un canal de comunicación permanente y que tiene como ventaja la inmediatez de la información con el público de la institución. CeNAT cuenta con un canal en Youtube, soundcloud, página de Facebook y el sitio web, que representan los canales institucionales los cuales brindan información a los diferentes segmentos.
En las redes del CeNAT se proporcionan contenidos de valor: informativo, educativo y que contribuya a promocionar las vocaciones científicas. Las publicaciones que se realizan son anuncios de los cursos o talleres virtuales, noticias del quehacer institucional, programas de becas CeNAT-CONARE, actividades de transferencia de conocimiento, proyectos de investigación, campañas digitales que se elaboran de diferentes temas.
Dentro del ecosistema digital, la página de Facebook se mantiene en crecimiento constante de seguidores, el público se estratifica en un 53,70% mujeres y 46,30% hombres.

Labor del CeNAT a través de los medios de comunicación
sociales
CeNAT Medios Digitales 20 Prensa Escrita 10 Radio Televisión 9 11 @
Redes
del
146




Para el 2023 se desarrollaron tres campañas:
Becas CeNAT-CONARE, proyectos de Investigación de las dependencias y Aniversario CeNAT








147

MÁS DE
15 MIL
Cantidad de seguidores
45.000 personas
Alcance promedio mensual de las publicaciones

14 MIL
MÁS DE likes a la página
49
Cantidad de países que siguen la página

Alcance del CeNAT a través de Facebook

Fuente: Información del año 2023 proporcionada por comunicación CeNAT.
*La cantidad de seguidores se ha generado de forma orgánica, sin recurrir al pago de publicidad de redes sociales. Corte al 31 de diciembre del 2023
**Corte al 31 de diciembre del 2023
149
Alemania
Argentina
Australia
Austria
Bolivia
Brasil
Bélgica
Canadá
Chile
Colombia
Corea del Sur
Costa Rica
Cuba
Dinamarca
Ecuador
Egipto
El Salvador


España
Estados Unidos
Filipinas
Francia
Guatemala
Honduras
Irak
Israel
Italia
Japón
México
Nicaragua
Nigeria
Noruega
Nueva Zelandia
Panamá
Paraguay
Países Bajos
Perú
Portugal
Puerto Rico
Reino Unido
República Checa
República Dominicana
Rusia
Siria
Suecia
Suiza
Turquía
Uruguay
Venezuela
Vietnam


Países que dan seguimiento al CeNAT a las actividades socializadas por Facebook 49
Fuente: Información del año 2023 proporcionada por comunicación CeNAT.
150



A continuación, se presentan los principales datos de información alcanzada, logros e impactos evidenciados por cada uno de los Laboratorios del CeNAT en el año 2023.
Recurso humano en el CeNAT
Fundación Centro de Alta Tecnología Funcionarios, colaboradores y becas Periodo 2023-2022
Funcionarios
Estudiantes colaboradores
Información del año 2023 proporcionada por los laboratorios y área del CeNAT.
Becas Total ORIGEN Fuente:
AÑO 2023 69 141 45 255 AÑO 2022 78 145 41 264 Variación % -13% -3% 9% -4%
255 151
AÑO 2023


Fuente: Información del año 2023 proporcionada por los laboratorios y área del CeNAT.
160 140 120 100 80 60 40 20 0 Funcionarios, colaboradores y becas 69 Funcionarios Año 2023 Año 2022 Estudiantes colaboradores Becas 78 -13% -2% 141 145 45 41 -3% 152

Indicadores 2023, según laboratorio y área del CeNAT
Fuente: Información del año 2023 proporcionada por los laboratorios y área del CeNAT.
Indicadores públicos y priv ados 2023 Indicador CNCA PRIAS GA LANOTEC CENIBiot Total Publicaciones 12 4 2 33 15 66 Transferencia de conocimiento 51 16 20 40 30 157 Pro yectos 15 11 7 36 26 95 Días de funcionamiento del clúster 365 - - - - 365 Horas uso del clúster 85363 - - - - 85363 Convenios 3 3 2 4 2 14 Apo yo a estudiantes 16 14 11 64 72 177
CeNAT
153





área del CeNAT. 12 4 0 50 100 150 200 250 300 350 400 Publ CNCA 154
Fuente: Información del año 2023 proporcionada por los laboratorios y
Sectores con los que el CeNAT se ha vinculado en los últimos 6 años
Identi cación de los sectores con los que se relaciona CeNAT a diciembre del 2023








Fuente: Análisis de la información proporcionada por los laboratorios del CeNAT, actualizado a diciembre 2023
Educación 2018 Social 2018 Salud 2018 Energético 2018 Agropecuario 2018 Local-municipalidades 2018 Aeroespacial 2018 Turismo 2018 Ambiental 2018 Alimenticio 2018 Tecnológico 2018 Seguridad Nacional 2018 Física médica 2018 Biodiversidad 2018 Desarrollo de fármacos 2018 Biorefinería/bioeconomía 2018 Dispositivos médicos 2018 Aeronáutica 2018 Acreditación 2019 Arte y cultura 2019 Deporte 2019 Textil 2019 Transporte 2020 Marino pesquero Hacienda 2021 Regulación 2021 2021 Forestal 2021 Innovación 2021 Banca y Finanzas 2022 Economía 2023
155
Instituciones nacionales que se incorporaron el año 2023 en las relaciones con el CeNAT


Inst. Nac. Innovación y Transferencia en Tecnol. Agropecuaria
CCSS
MEP

MICIT - CONICITT

Universidades Públicas
ECALACOMET
Aviación Civil
CNFL
CINDE
LANAMNE
M. de la Presidencia
MINAE
MAG INEC
MEIC
Ministerio de Salud Banco Popular Estado de la nación
Recope

COMEX
M. REECancillería
Ministerio de Justicia
Ministerio de Vivienda y Asentamientos Humanos (MIVAH)
SENARA

Colegios Profesionales
BCCR
Acueductos y Alcantarillados AyA
ICE
Hacienda
INA
Centro Nacional de Alta Tecnología CeNAT


Procomer
Fuente: Análisis de la información proporcionada por los laboratorios del CeNAT, actualizado a diciembre 2023

156
Instituciones, organizaciones y empresas vinculadas con el CeNAT en el año 2023










Fuente: Análisis de la información proporcionada por los laboratorios del CeNAT, actualizado a diciembre 2023
CeNAT MEIC MINAE MAG Ministerio de Salud ICE INA Universidades Públicas Aviación Civil ECA-LACOMET INEC CCSS Ministerio de Jus�cia Cámara TIC Colegios profesionales SENASA SCALAC MEP MICITT CONICIT BCCR CSUCA Ins�tuto Meteorológico ICAFE CORFOGA CANAPALMA COMEX CINDE Procomer CANAPEP Cámara de Turismo Banco Popular CNFL Hacienda Armada USA Cámara de Industrias Colegio de Agróno mos Bri�sh Columbia University UCIMED Meryland University NASA Servir NATGEO JUPEMA Liberty AMEXCID BANCO NACIONAL ENAPROC CoopeAgri CoopeVictoria Red Educadores Ambientales
Incorporadas en el año 2020
Inst. Innovación y Transferencia en Tecnol. Agropecuaria
Asentamientos
000
Incorporadas en el año 2019 Presentes en el año 2018 Incorporadas en el año 2021 Incorporadas en el año 2023 Incorporadas en el año 2022
Ministerio de Vivienda y
Humanos [MIVAH]
Calidad del Trabajo
Percepción de lo que han realizado las instituciones con el CeNAT
Alianzas estratégicas
Acción Social
Servicios científicos
Publicación científica Cooperación / colaboración
Cooperación interuniversitaria
Eficiciencia en la gestión
Soluciones estratégicas
Innovación y desarrollo
Fuente: Análisis de la información proporcionada por los laboratorios del CeNAT, actualizado a diciembre 2023
 Ente articulador
Ente articulador
158
Diseños científicos
CeNAT
Centro Nacional
Lo que las instituciones esperan del CeNAT
CeNAT a la vanguardia en investigación
CeNAT como aliado para cumplir objetivos institucionales
CeNAT que apoya metas país
CeNAT que apoye en la confiabilidad del dato
CeNAT en el desarrollo de proyectos conjuntos
CeNAT en la formación científica
CeNAT en el fortalecimiento de las relaciones institucionales

CeNAT como una institución innovadora
CeNAT realizando investigación conjunta
CeNAT más próximo a la academia
CeNAT como organizador de eventos científicos
CeNAT en la participación en proyectos internacionales
CeNAT en publicaciones conjuntas
CeNAT en la soluciones a problemas globales
CeNAT socializando el uso de la información
Fuente: Análisis de la información proporcionada por los laboratorios del CeNAT, actualizado a diciembre 2023
CeNAT en la publicaciones científicas
CeNAT en la relación científicamente correcta
CeNAT en servicios de fondos PINN
CeNAT con relación permanente
CeNAT en el escalamiento de transferencia tecnológica
CeNAT en proyectos de investigación
CeNAT no compita por fondos de investigación
CeNAT como alianzas estratégicas
CeNAT en colaboraciones efectivas
159

Ilustración 8. Mapa mundial del alcance que tiene el CeNAT al 2023









 Fuente: Análisis de la información proporcionada por los laboratorios del CeNAT, actualizado a diciembre 2023
Fuente: Análisis de la información proporcionada por los laboratorios del CeNAT, actualizado a diciembre 2023
160

Tabla 1. Mapa mundial del alcance de los laboratorios del CeNAT al 2023
Alemania Argentina Australia Belice Brasil Canadá Chile China Colombia
Ecuador
El Salvador España
Estados Unidos Francia
Guatemala Honduras
Inglaterra
Israel
Italia Japón México
Nicaragua Panamá
Perú
Reino Unido
Serbia
Suiza Turquía
Uruguay
Venezuela
Fuente: Análisis de la información proporcionada por los laboratorios del CeNAT, actualizado a diciembre 2023
CENIBIOT X X X X X X X X X X X X X X X X LANOTEC X X X X X X X X X X X X GESTIÓN AMBIENTAL X X X X X X X X X X X X X X X X X X PRIAS X X X X X X X X X X X X X X X CNCA X X X X X X X X X X X X X X X X X X 161


Impacto en el 2023 por el CeNAT

MÁS DE
15 mil
45.000 PERSONAS
49
50

Seguidores en Facebook
Promedio del alcance anual de las publicaciones en Facebook
Nacionalidades de seguidores en Facebook
Presencia en medios de comunicación

5 Patentes inscritas
7 Procesos de registro
2 Investigadores en el registro de inventores de Estados Unidos
163



66 Publicaciones Científicas

177
Estudiantes pasantes en proyectos de desarrollo académico
95
Proyectos desarrollados en el marco de la triple hélice: Académica, Gobierno y Sector Privado

45
Becas en el marco del Programa Becas CONARE-CeNAT

365 días de funcionamiento del clúster
634
cuentas con acceso a los servicios de infraestructura computacional
85363 horas ciencia en simulaciones y procesamiento de datos
157 Transferencias de conocimiento
9963 Población beneficiada
7 Olimpiadas Química que apoya el CeNAT
Impacto en el 2023
164
9000
asistencia técnica a productores en variabilidad y cambio climático
28 apoyo a organismos o instituciones de investigación ciencia aplicada
45 apoyo a empresas de investigación ciencia aplicada
14 convenios
26 articulaciones con sectores estratégicos
29 vinculación con redes interinstitucionales
30 países con vinculación con el CeNAT



5
Eduroam desplegados en las sedes y recintos de las 5 Universidades Públicas
6
157316
estudiantes y profesores de Universidades Públicas con acceso a la red Eduroam

105
Países con Eduroam
servicios de la red a disposición de estudiantes, funcionarios y profesores
7.5
billones
autenticaciones de la Eduroam en territorios internacionales

Fuente: Información del año 2023 proporcionada por los laboratorios y área del CeNAT.

165

FunCeNAT y Resultados Financieros
La Fundación Centro de Alta Tecnología (FunCeNAT) es creada por Ley de la República No. 7806, del 25 de mayo de 1998, con el propósito de administrar los recursos y la atención de los fines institucionales del Centro Nacional de Alta Tecnología (CENAT).
Artículo 3.- El Estado y sus instituciones quedan autorizados para traspasar recursos al Centro Nacional de Alta Tecnología, de cuya administración y manejo será responsable la Fundación Centro de Alta Tecnología.
La FunCeNAT cuenta con la supervisión permanente de la Contraloría General de la República, en lo relacionado al adecuado manejo y administración de los recursos que se reciban bajo la vigencia de la Ley 7386. De igual manera recibe auditorías especiales de la Auditoría del CONARE, y cuenta con auditorías anuales de una forma externa.

1998 reconoció expresamente en FUNCENAT la entidad que mantendría el deber legal de administrar los recursos requeridos para la ejecución de los proyectos desarrollados por medio del CENAT.
Por su parte, la Fundación cuenta con una Junta Administradora, la cual está integrada por representantes de las Instituciones de Educación Superior Universitaria Estatal (IESUE), el Gobierno Local (Municipalidad) y del Gobierno de la República. La Junta nombra a un director ejecutivo encargado de la FunCeNAT.
Es importante indicar que al momento de crear el CENAT, dentro del contexto legal, los rectores de las universidades integrantes del CONARE crear juntamente con el CENAT la Fundación Centro de Alta Tecnología (FUNCENAT). Esta fundación atiende las especiales características del CENAT en los aspectos propios de su estructura, así como el régimen legal previsto. La Ley Nº 7806 del 25 de mayo de
La Fundación funciona para el CeNAT como una plataforma de servicios que atiende las necesidades del CeNAT, así como los proyectos públicos y privados que administra. Por lo que la FunCeNAT colabora en forma activa en el quehacer de las áreas, laboratorios, programas y proyectos, brindando un sostén en la gestión administrativa en forma eficiente y transparente, apoyo en la sana gestión financiera, en el desarrollo organizacional a nivel nacional e internacional, así como el soporte legal en las acciones que emprenden los Laboratorios, Programas y Proyectos.
Fortaleciendo el vínculo con el CONARE, además de apoyar la comunicación y articulación intersectorial.
167



Siempre alineando todas sus actividades a las directrices emitidas por CONARE, por su Junta Administrativa, por la Contraloría General de la República, por la auditoría de CONARE, así como por la Auditoría Externa, de forma que sus actividades y acciones se apeguen a las leyes, reglamentos y normativas que corresponden.
La FUNCeNAT, es la fundación que gestiona un apoyo permanente a los laboratorios y programas del CeNAT en 4 pilares para el desarrollo organizacional, estos son:
Gestión Administrativa
Gestión del Talento Humano
Gestión Legal
Gestión financiera y captación
Ciencia e Ingeniería de Materiales Biotecnología


A continuación, se presenta una estructura operativa que expone el funcionamiento del CeNAT.
CeNAT
Director General del CeNAT
Computación Avanzada


Gestión Ambiental
LANOTEC CENIBiot CNCA PRIAS Agromática Observatorio Climático



FunCeNAT
Junta Directiva FunCeNAT

Ciencia, Cultura y Sociedad
Dirección Ejecutiva FunCeNAT

Gestión Administrativa
Gestión Financiera y captación
Gestión Desarrollo Organizacional
Gestión Legal
168


INFORME DE LOS AUDITORES INDEPENDIENTES SOBRE LOS ESTADOS FINANCIEROS RESUMIDOS
A la Junta Administradora de la Fundación Centro de Alta Tecnología (FunCeNAT).
Los estados financieros resumidos adjuntos, que comprenden el estado de posición financiera resumido al 31 de diciembre de 2023 y el estado resumido de excedentes, por el año que terminó en esa fecha , así como las correspondientes notas explicativas, se derivan de los estados financieros auditados de la Fundación Centro de Alta Tecnología (FunCeNAT) (“la Fundación”) correspondientes al año terminado en dicha fecha En nuestro informe del 19 de marzo de 2024 hemos expresado una opinión favorable sobre dichos estados financieros Dichos estados financieros, así como los estados financieros resumidos, no reflejan los efectos de hechos que hayan ocurrido con posterioridad a la fecha de nuestro informe sobr e los estados financieros auditados.
Los estados financieros resumidos no contienen toda la información que requiere n las Normas Internacionales de Información Financiera para Pequeñas y Medianas Empresas para la preparación de los estados financieros auditados de la Fundación Centro de Alta Tecnología (FunCeNAT) En consecuencia, la lectura de los estados financieros resumidos no equivale a la lectura de los estados financieros auditados de la Fundación Centro de Alta Tecnología (FunCeNAT).
Responsabilidad de la dirección en relación con los estados financieros resumidos
La Administración es responsable por la preparación y presentación razonable de los estados financieros de conformidad con las Normas Internacionales de Información Financiera para Pequeñas y Medianas Empresas y por aquel control interno que la Administrac ión determine necesario para permitir la preparación de estados financieros que estén libres de errores materiales, ya sea debido a fraude o error no relacionado con fraude.
Responsabilidad del auditor
Nuestra responsabilidad es expresar una opinión sobre los estados financieros resumidos basada en nuestros procedimientos realizados de conformidad con la Norma Internacional de Auditoría (NIA) 810 “Encargos para informar sobre estados financieros resumido s”

Despacho Contadores Públicos Santo Domingo Heredia Apartado Postal 128-3100 +506-88391469 +506-88359996
DC-ALLIANCE
170

Opinión
En nuestra opinión, los estados financieros resumidos derivados de los estados financieros auditados de la Fundación Centro de Alta Tecnología (FunCeNAT) para el año que terminó 31 de diciembre de 2023 son congruentes, en todos los aspectos materiales con dichos estados financieros, de conformidad con las Normas Internacionales de Información Financiera para Pequeñas y Medianas Empresas
Licda. Zorahyda Vargas V.- C.P.A. No. 4204
Póliza No.0116 FIG 7
Vence: 30 de setiembre de 2024
Timbre de Ley No.6663, ¢1.000
Adherido y cancelado en el original
19 de marzo de 2024


Despacho Contadores Públicos Santo Domingo Heredia Apartado Postal 128-3100 +506-88391469 +506-88359996
DC-ALLIANCE
171




FUNDACIÓN CENTRO DE ALTA TECNOLOGÍA (FunCeNAT)
ESTADOS RESUMIDOS DE POSICIÓN FINANCIERA
AL 31 DE DICIEMBRE DE 2023 Y 2022Y EL 1 DE ENERO DEL 2022 (Reestructurados) (Cifras Expresadas en Colones Costarricenses)




2023 2022 (Reestructurado) 01/01/2022 (Reestructurado) ACTIVO ACTIVOS CORRIENTES Efectivo y Equivalentes de Efectivo ¢ 102.938.521 ¢ 17.356.247 ¢ 131.407.809 Inversiones mantenidas hasta su vencimiento 457 638 814 260 273 653 524 474 251 Intereses por cobrar sobre inversiones 20.066.474 21.829.069 18.363.673 Cuentas por cobrar 17 743 157 34 489 650 62 984 189 TOTAL ACTIVO CIRCULANTE 598.386.966 333.948.619 737.229.922 Inversiones mantenidas hasta su vencimiento 1.845.873.090 1.886.650.771 2.064.571.557 Equipo de Cómputo . neto 824.892 1.376.346 1.927.800 TOTAL DE ACTIVOS ¢2.445.084.948 ¢2.221.975.736 ¢2.803.729.279 PASIVOS Y ACTIVOS NETOS PASIVOS Cuentas por pagar y gastos acumulados ¢ 125 506 227 ¢ 39 692 996 ¢ 63 650 571 Fondos Restringidos Públicos 1.435.815.380 1.361.793.396 1.750.419.058 Fondos Restringidos Privados 655.443.141 634.485.777 753.191.011 Total del Pasivo 2.216.764.748 2.035.972.169 2.567.260.640 Activo Neto Superávit Acumulados 186.003.567 236.468.639 209.805.870 Superávit o (déficit) del periodo 42.316.633 (50.465.072) 26.662.769 Total de Activos Netos 228.320.200 186.003.567 236.468.639 TOTAL DE PASIVOS Y ACTIVOS NETOS ¢2.445.084.948 ¢2.221.975.736 ¢2.803.729.279 172
FUNDACIÓN CENTRO DE ALTA TECNOLOGÍA (FunCeNAT)

ESTADOS RESUMIDOS DE EXCEDENTES
POR LOS AÑOS QUE TERMINARÓN EL 1 DE DICIEMBRE DE 2023 Y 2022 (Restructurado) (Cifras Expresadas en Colones Costarricenses)

2023 2022 (Reestructurado) INGRESOS: Intereses sobre inversiones ¢ 74.466.899 ¢ 67.407.535 Intereses por Administración de Proyectos 146 502 142 35.377.076 Total de Ingresos 220.969.041 102.784.611 GASTOS: Gastos generales y administración 159.185.419 165.643.607 Diferencial cambiario-neto 19 548 373 (3.511.989) Otros Gastos/ Ingresos (81.384) (8.881.935) Subtotal 178 652 408 153.249.683 EXCEDENTE (DEFICIT) DEL PERÍODO ¢ 42.316.633 ¢ (50.465.072)
173




Consejo Nacional de Rectores

Dr. Emmanuel González Alvarado
Rector Universidad Técnica Nacional
Dr. Gustavo Gutiérrez Espeleta
Rector Universidad de Costa Rica
Ing. María Estrada Sánchez MSc.
Rectora Instituto Tecnológico de Costa Rica
Rector Universidad Nacional

M.Ed. Francisco González Alvarado
M.B.A. Rodrigo Arias Camacho
Rector Universidad Estatal a Distancia


175
Consejo
Cientifico
M.Sc. Lilliana Rodríguez Barquero
Universidad Técnica Nacional
Dra. María Laura Arias Echandi
Universidad de Costa Rica
Dra. Floria Roa Gutiérrez
Instituto Tecnológico de Costa Rica
Dr. Ing. José Luis León Salazar
Instituto Tecnológico de Costa Rica
Dr. Jorge Herrera Murillo
Universidad Nacional
PhD. Rosibel Víquez Abarca
Universidad Estatal a Distancia


176

Aliados Estratégicos







Universidad de Costa Rica
Instituto Tecnológico de Costa Rica





Universidad Nacional
Universidad Estatal a Distancia

Universidad Técnica Nacional
Promotora Costarricense de Innovación e Investigación
MICITT
177






Junta Administradora de la Fundación Centro de Alta Tecnología

Presidente: MBA. Rodrigo Arias Camacho
Secretario: Dr. Emmanuel González Alvarado
Tesorero: Dr. Gustavo Gutiérrez Espeleta
Vocal 1: Rose Marie Ruiz Bravo
Vocal 2: Marielos Aldi Villalobos

Fiscal Primero: Máster Jorge Chaves Arce
Fiscal segundo: MBA. Francisco González Alvarado
Director CeNAT: Ing. Eduardo Sibaja Arias
Asesor Legal OPES-CONARE:
Lic. Gastón Baudrit Ruiz

178
Dirección CeNAT

Ing. Eduardo Sibaja Arias, MBA
Director CeNAT
Bach. Karol Palma Odio
Asistente Administrativa de la dirección




Directores de Laboratorio
Dr. José Vega Baudrit
Director del Laboratorio Nacional de Nanotecnología
Dr. Randall Loaiza Montoya
Director del Centro Nacional de Innovaciones Biotecnológicas
Dr. Esteban Meneses Rojas
Director Colaboratorio Nacional de Computación Avanzadas
Ing. Allan Campos Gallo, MBA
Director Area Gestión Ambiental
Ing. Cornelia Miller Granados, MBA
Directora Laboratorio PRIAS
179
Funcionarios

CeNAT
Melinda Corrales Ramírez
Rubén Padilla Hernandez
Sugey Rivera Obando Andreina Leal Sánchez
Fabián Ramírez Villalobos
CeNAT -Gestión Ambiental
CeNAT
CeNAT
CeNAT
CeNAT-PRIAS
180


Rebeca Rodríguez Fonseca
Charys López Borbón

Anthony Mayorga Hernández



LANOTEC



Fabiola Rodríguez Ulloa
Andrea Araya Sibaja
Diego Batista Menezes
Gabriela Montes de Oca Vásquez
Juan Miguel Zúñiga Umaña
Melissa Camacho Elizondo
Reinaldo Pereira Reyes
Rebeca Corrales Brenes
Sergio Paniagua Barrantes
Yendry Corrales Ureña
Susana Mesén Porras
Claudia Chaves Villarreal
Daniela Zúñiga Rivera
Andrea Rivera Álvarez
181

CNCA

Melissa Hernández Sánchez
CNCA
Fabricio Quirós Corella
CNCA
Carlos Gamboa Venegas
CNCA-RED CONARE
Melany Calderón Osorno
CNCA-CENIBiot
Edward Soto Castro
CNCA
Christian Asch Burgos
CNCA
Herson Mena Mora
CNCA
Johansell Villalobos Cubillo
CNCA
Isaí Ugalde Araya
CNCA-RED CONARE


182

PRIAS

Heileen Aguilar Arias
Iván Ávila Pérez
Stephanie Leitón Ramírez
Milagro Jiménez Rodríguez
Christian Vargas Bolaños
Mariana Ávila Ruiz
Jose Umaña Ortiz
Fabián Ramírez Villalobos PRIAS PRIAS PRIAS PRIAS PRIAS PRIAS PRIAS CeNAT-PRIAS
183

CENIBiot


Max Chavarría Vargas

Emmanuel Araya Valverde
Pamela Alfaro Vargas
Jose Pablo López Gómez
Jonathan Parra Villalobos
Vanessa Maria Rivera Mora
Rachel Ardón Rivera
Erika Barrantes Murillo
Silvia Elena Fernández Fernández
Melissa González Sanabria
Valeria Leandro Arce
Cristofer Orozco Ortiz
Natalin Picado Canales
Douglas Alberto Venegas González


Daniela Wicki Emmenegger
Yosimar González Fernández
Alina Gamboa Villalobos
Esteve Mesén Porras
Luis Diego Hidalgo Badilla
María Paula Valverde Mora
Isaac Delgado Quirós
Katherine Alfaro Bolaños
Jonathan Cortés Oviedo
Melany María Calderón Osorno




184
Coordinadora de Programa


Patricia Sánchez Trejos Agromática, Seguridad Alimentaria y Slow Food
Jazmín Calderón Quirós

Estado de la Nación
Gustavo Rojas Godínez
Erick Rojas Zuñiga
Maria Camila Aguilar Gomez
Sebastián González Rosales
José Mario Achoy Sánchez
185
FunCeNAT
Cynthia Cordero Solís, MBA Directora Administrativa
Mauricio Segura Chacón
Jeannette Vargas Arce
Yakelyn Bejarano López
Margarita Quan Zepeda
María Fernanda Hernández Jiménez
Carolina Morales Cerdas

Paula Valverde Mora


186
Becados y colaboradores
Sheila Jiménez Mesén
Valeria Rojas Chinchilla
Antony Torres Solano
David Araya Gutiérrez
Dilan Rojas Saborío
Geisel Cabrera Lazo
Johana Valera Rangel
Lucia Noboa Jiménez
Randall Hidalgo Sánchez
Universidad de Costa Rica (UCR)
Universidad Nacional de Costa Rica (UNA)
Universidad de Costa Rica (UCR)
Tecnologico de Costa Rica (TEC)
Universidad Nacional de Costa Rica (UNA)
Universidad Nacional de Costa Rica (UNA)
Universidad de Costa Rica (UCR)
Universidad de Costa Rica (UCR)
Universidad de Costa Rica (UCR)
CENIBiot
CENIBiot
CENIBiot
CENIBiot
CENIBiot
CENIBiot
CENIBiot
CENIBiot
CENIBiot

Carlos Pasquier Jaramillo
Eduardo Aguilar Bejarano
Esteban Bertsch Aguilar
Dorian Rojas Villalta
Isaura Gutiérrez Vargas
Julián Sánchez Castro

Universidad de Costa Rica (UCR)
Universidad de Costa Rica (UCR)
Universidad de Costa Rica (UCR)
Tecnologico de Costa Rica (TEC)
Universidad de Costa Rica (UCR)
Tecnologico de Costa Rica (TEC)
CNCA CNCA CNCA CNCA CNCA 187
CNCA



Andrea Rivera Álvarez
Fiorella Calderón Jiménez
Karina Ramírez Monge
Vanessa Morales Cerdas

Universidad de Costa Rica (UCR)
Tecnologico de Costa Rica (TEC)
Universidad de Costa Rica (UCR)
Universidad de Costa Rica (UCR)




Ana Carlota Reyes Rufino
Estefanie Tatiana Grant Rogers
Jean Carlo Guerrero Piña
Keylan Simmons Coto
Ricardo Quesada Grosso
Lisa Stephanie Badilla Vargas
Karina Ramírez Monge
Paola Sanchez Navarro

Universidad de Costa Rica (UCR)
Universidad de Costa Rica (UCR)
Tecnologico de Costa Rica (TEC)
Universidad de Costa Rica (UCR)
Universidad de Costa Rica (UCR)
Universidad de Costa Rica (UCR)
Universidad de Costa Rica (UCR)
Universidad de Costa Rica (UCR)

LANOTEC
LANOTEC
LANOTEC
LANOTEC
LANOTEC
LANOTEC
LANOTEC
LANOTEC
Javier Chinchilla Orrego
Jordan Hernández Ledezma
Luis Diego Mora Araya
Sebastián Moya Salas
Laura Rojas Artavia

Karen Salazar Barrantes
Michael Solano Rojas

Universidad de Costa Rica (UCR)
Universidad Estatal a Distancia (UNED)
Universidad de Costa Rica (UCR)
Universidad de Costa Rica (UCR)
Universidad de Costa Rica (UCR)
Universidad de Costa Rica (UCR)
Universidad de Costa Rica (UCR)


LANOTEC
LANOTEC
LANOTEC
LANOTEC
LANOTEC
LANOTEC
LANOTEC

GA GA GA GA
188

Fabiola Solano Cerdas
Shirley Méndez Cordonero
Andrea Hidalgo Piedra
Hanzel León González
Róger Hernández Jiménez
Michael Quesada Valverde
Adolfo Piedra Mora
Brayan Rodríguez
Tecnológico de Costa Rica (TEC)
Universidad Nacional de Costa Rica (UNA)
Universidad de Costa Rica (UCR)
Tecnológico de Costa Rica (TEC)
Universidad de Costa Rica (UCR)
Universidad de Costa Rica (UCR)
Universidad de Costa Rica (UCR)
Universidad Estatal a Distancia (UNED) PRIAS PRIAS PRIAS PRIAS PRIAS PRIAS PRIAS PRIAS
189
Colaboradores

CENIBiot

Verónica Ramos Salazar
María Torres Hidalgo
Jazmín Calderón Quirós
Hazel Alvarado Pérez
Darling Mora Rojas
Daniela Lai Sánchez
Camille Bernand-Pardell
Brayan Villalobos Quintanilla
Bayron Leiva Gamboa
Paula Chiví Ramírez
Luis Hidalgo Badilla
Dessiré Arrieta Murillo
Yili Liang Wu
Alison Salas Campos
Montserrat Mendoza Salas
Michelle Montero Quesada
Jonathan Sánchez Vargas
Andrés Hernández León
Daniela Víquez Espinosa
Maria Paniagua Rojas
Maricruz Monge Mora
Alexis Jerez Navarro
Esteban Escalante Campos
Andrea Calvo Obando
Sofía Trejos Valverde
Ariana Herrera Quesada
Bethania Zamora Zuñiga
María Henríquez Granados
Mauro Jiménez Gonzalez
Diana Vargas Hernández
Noelia Rechnitzer Sandí
Priscila Campos Astorga
Andrés González Vega
Victor Víquez Muñoz
Sharon Chacón Vargas
María Gómez Bogantes
Allan Artavia León
Ashelee Sosa Cordero
David Morera Uribe
Karla Montero Castro
Raquel Jiménez Umaña
Meilsey Godínez Portuguez
Cristopher Arguello Rivera
Ariel Arroyo Chaves
Diógenes López Barrantes
Juan Ignacio Garro Rodríguez
Kevin Segura Rodríguez
Mariana Campos Hernández
Montserrat Mendoza Salas
Ashly Bolaños Umaña
Kenneth Solís Morales
Andrés Abarca Herrera
Karol Aguilar Guerrero
Michelle Montero Quesada
Adrián González Jiménez
Jennifer Calvo Alemán.
Mariana Elizondo Blanco
Alexander Monge Zuñiga
Monzerrat Sánchez Salas
Efraín Escudero Leiva
190
CNCA

José Daniel Amador Salas
Kevin José Facey Torres
Josef Ruzicka González
Dorian Rojas Villalta
Adrián González Jiménez
Antonio Piedra Pacheco
Fernando Herrera Valverde
Mariel Chacón Sánchez
Danniela Cartín Quesada
Juan Pablo Ureña Madrigal

GESTIÓN AMBIENTAL
Jazmín Calderón Quíros
Daniel Serrano Delgado
Miranda Sánchez Zamora
Jazel Domínguez Alvarado
Siony Calvo Brenes
Mirsa Domínguez Alvarado
Marina Ortega Gutiérrez
Martha Montero Vindas
Wenfry Grijalba Villegas
191
LANOTEC

Mauricio Vallejo
Michelle Gutiérrez Campos
Mónica Alfaro Porras
Sara Montero Vargas
Christopher Arguello Rivera
Amanda Sofía Calderón Campos
Catalina Alvarado Jiménez
Ernesto Villegas Villegas
Jeshua Acuña Matamoros
José Pablo Chávez Pérez
Juan Pablo Carballo Gonzales
Kolleen María Alvarado Rodríguez
Tracy Cambronero Sibaja
Valery Torres Garita
Paola Céspedes Ajún
María Francinie Guevara Hidalgo
Esteban Mena Porras
Annaby Contreras Aleman
Dennise Paola Murillo Sojo
Gabriel Abarca Hidalgo
Andrés Chinchilla Velhagen
Jimena Arias Ulloa
Jose Alejandro Rojas Hidalgo
Isaac Portobanco Villalobos
Jose Pablo Alvarado Espinoza
Julián de Jesús Morales Monge
Sergio Bernabé Velásquez Garnica
Alejandro Ureña Clarke
Kevin Segura Rodríguez
Sara Cordero Fuentes
Iván Solís Sandí
Yeymi Torres Sequeira
Fabricio Chaverri Segura
Andrea Rivera Álvarez
Tamara Quesada Soto
Daniela Zúñiga Rivera
Kenia Blandón Bolaños
Camilo José Zapata Segura
Sergio Solano Calderón
Christopher Murillo Bolaños
Carlos Valenciano Elizondo
Daniel Esteban Rojas Pérez
Daniel Portuguez Molina
Steven David Ceciliano Castro
Nicole Vílchez Mejías
192

PRIAS
Andrés Aguilar Carboni
Manuel Calderón Rodríguez
Natalia Martínez Rojas
ESTADO DE LA NACIÓN
Marines Álvarez Fallas
Ludwing Hall Romero
Yahaira Araya Porras
Stephanie Castro Jiménez
Aaron Barquero Salas
Mario Cortés Vásquez
Kevin Mora Ávila
Christian León Trigueros
Andrea Marín Bolaños
Lisbeth Bonilla Cruz
Walter Pereira Vargas
Luis Gamboa Calvo
Lucía Elizondo Sancho
Fabiana Conejo Arias
Juan Ignacio Sandoval
193



1.3 km. norte de la Embajada de los Estados Unidos. Pavas, San José, Costa Rica (506) 2519-5835 | Fax: (506) 2232-0423 cenat@cenat.ac.cr www.cenat.ac.cr /centro.nacional.de.alta.tecnologia Transformando conocimiento Centro Nacional de Alta Tecnología en desarrollo MEMORIA CeNAT 2023

Ente articulador
Ente articulador











 Fuente: Análisis de la información proporcionada por los laboratorios del CeNAT, actualizado a diciembre 2023
Fuente: Análisis de la información proporcionada por los laboratorios del CeNAT, actualizado a diciembre 2023




















































































































